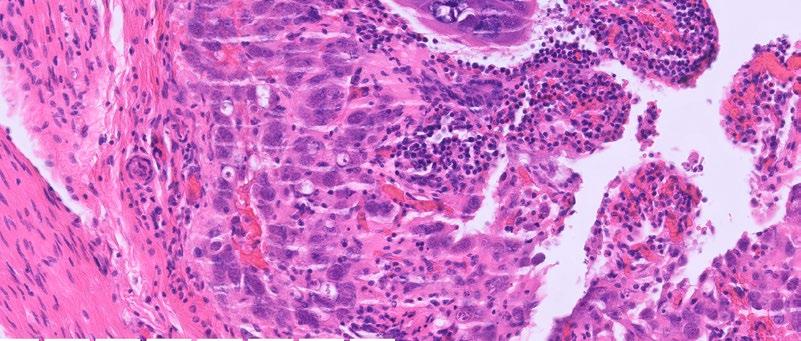

Issue 322 | March 2026
Control & Th erapy Series
PUBLISHER
Centre for Veterinary Education
Veterinary Science Conference Centre
Regimental Drive
The University of Sydney NSW 2006 + 61 2 9351 7979 cve.marketing@sydney.edu.au cve.edu.au
Print Post Approval No. 10005007
CVE Director
Associate Professor Kate Patterson kate.patterson@sydney.edu.au
EDITOR
Lis Churchward elisabeth.churchward@sydney.edu.au
VETERINARY EDITOR
Dr Richard Malik
VETERINARY SUB-EDITOR
Dr Jo Krockenberger joanne.krockenberger@sydney.edu.au
DESIGNER
Samin Mirgheshmi
ADVERTISING
Lis Churchward elisabeth.churchward@sydney.edu.au
To integrate your brand with C&T in print and digital and to discuss new business opportunities, please contact: MARKETING & SALES MANAGER
Ines Borovic ines.borovic@sydney.edu.au
DISCLAIMER
All content made available in the Control & Therapy (including articles and videos) may be used by readers (You or Your) for educational purposes only.
Knowledge and best practice in this field are constantly changing. As new research and experience broadens our knowledge, changes in practice, treatment and drug therapy may become necessary or appropriate. You are advised to check the most current information provided (1) on procedures featured or (2) by the manufacturer of each product to be administered, to verify the recommended dose or formula, the method and duration of administration, and contraindications.
To the extent permitted by law You acknowledge and agree that:
I. Except for any non-excludable obligations, We give no warranty (express or implied) or guarantee that the content is current, or fit for any use whatsoever. All such information, services and materials are provided ‘as is’ and ‘as available’ without warranty of any kind.
II. All conditions, warranties, guarantees, rights, remedies, liabilities or other terms that may be implied or conferred by statute, custom or the general law that impose any liability or obligation on the University (We) in relation to the educational services We provide to You are expressly excluded; and III. We have no liability to You or anyone else (including in negligence) for any type of loss, however incurred, in connection with Your use or reliance on the content, including (without limitation) loss of profits, loss of revenue, loss of goodwill, loss of customers, loss of or damage to reputation, loss of capital, downtime costs, loss under or in relation to any other contract, loss of data, loss of use of data or any direct, indirect, economic, special or consequential loss, harm, damage, cost or
(including
The Control & Therapy Series was established in 1969 by Director Dr Tom Hungerford. His aim was to publish uncensored and unedited material contributed by vets writing about:
...not what he/she should have done, BUT WHAT HE/ SHE DID, right or wrong, the full details, revealing the actual “blood and dung and guts” of real practice as it happened, when tired, at night, in the rain in the paddock, poor lighting, no other vet to help.
The C&T forum gives a ‘voice’ to the profession and everyone interested in animal welfare. You don’t have to be a CVE Member to contribute an article or reply to a 'What's YOUR Diagnosis?'. We welcome contributions from Vets, Techs, Nurses, allied professionals and anyone interested in animal welfare—Non CVE Members included.
Submit your C&T article
A template and information about uploading high resolution images for print can be found here cve.edu.au/submit-article
Questions?
Please contact cve.marketing@sydney.edu.au
Join In!
The C&T is not a peer-reviewed journal. Rather, it is a unique forum allowing veterinary professionals to share their cases and experiences with their colleagues. We are keen on publishing short, pithy, practical articles (a simple paragraph is fine) that our members/readers can immediately relate to and utilise. Our editors will assist with English and grammar if required.
I enjoy reading the C&T more than any other veterinary publication.
-Terry King, Veterinary Specialist Services, QLD
Thank You to All Contributors & Advertisers
The C&T Series thrives due to your generosity.
Major Winners
Prize: A CVE$500 voucher
—Christopher Simpson page 3
Winners
Prize: A CVE$300 voucher
—Alex Moore page 8
—Rebecca Tsai & Marcus Gunew page 12
—Theodora Kletsas page 22
—Cathie Harvey & Jeremy Rogers page 32
Best Visuals
Prize: A CVE$300 voucher
—Shannon Lee page 43


This issue of C&T brings together a mix of practical insights and thought-provoking perspectives—some of which may feel unexpectedly timely. That sense of 'this is exactly what I needed right now' is not accidental. In adult learning, relevance and timing are powerful; when ideas align with real clinical experience, they are far more likely to influence practice.
For that reason, I encourage you to return often—not only to this issue, but to past editions. The value of professional learning is rarely linear; sometimes the most meaningful insight is one you weren’t ready for the first time.
A quiet theme throughout this issue is the importance of thinking beyond the immediate context. As Andrea Harvey highlights in a comment about this month’s Perspective on page 42, concepts that appear specific to one species or scenario are rarely confined to that space. The opportunity lies in applying ideas more broadly across veterinary practice.
This issue also brings active discussion and respectful debate. I believe we have both a responsibility and a privilege to bring forward complex, and sometimes uncomfortable, conversations. Our role is not to tell the profession what to think, but to create a credible, evidence-informed space where diverse perspectives can be explored respectfully.
I hope you enjoy this issue—and we’re already hard at work curating the fantastic content that’s coming together for the editions ahead.

Associate Professor Kate Patterson Director
The prize is a CVE$500 voucher
Dr Christopher Simpson BVSc MANZCVSc
Victoria Veterinary Clinics
Hong Kong
e. simpson_christo@icloud.com
C&T No. 6112

Dr Christopher Simpson is a graduate of The University of Melbourne, but has practiced in Melbourne, Sydney, Canberra, the US, the UK, and even the South Pacific island of Vanuatu! Since 2015, however, he has found his spiritual home in Hong Kong, where he is attracted to the thrilling pace of life, Cantonese food, language, trail-running, and of course the fascinating caseload that only tropical Asia can offer! He is a member of the Australian & New Zealand College of Veterinary Scientists, has completed a Residency in Small Animal Internal Medicine at Melbourne University, and contributed scientific papers to the Australian Veterinary Journal, the Journal of Feline Medicine and Surgery, and several veterinary textbook chapters. He is also a regular contributor to the Control & Therapy Series and enjoys sharing the rich and varied experiences of practicing in Hong Kong.

Tabasco is an 11-year-old Male neutered cross breed dog who presented to our clinic for dermal nodule on the face (see Figure 1)
We advised the options for diagnosis were either FNA, or incisional or excisional biopsy.
The owners were keen to avoid surgery in this case as they had had multiple benign lumps removed from Tabasco’s body a year previously.
In their opinion the dog had taken a long time to fully recover from that surgery. Additionally, they did not want the dog to have any surgery on the face, as they considered this to be potentially more uncomfortable for the dog, and they were worried about complications.
FNA was supportive of a mast cell tumour (MCT) (see figure 2).
Although there are some reports suggesting criteria for MCT grading based on cytology, that was not considered a valid option in this case due to a relatively small cell recovery. A basic staging, consisting of physical examination of the local lymph nodes and a set of chest x-rays, did not reveal any obvious evidence of metastatic spread.
Provisionally, this was therefore considered an ungraded MCT without obvious evidence of metastatic spread on basic staging work-up.
Given that the owners ruled out the option of surgery, we discussed the option of Stelfonta® use in this case.
Stelfonta® (tigilanol tiglate) is product registered for treatment of non-metastatic cutaneous MCTs located anywhere on the dog’s body, and subcutaneous MCTs located on the legs at or below the elbow or hock.


The product is an injection to be given intralesionally with a dose determined by calculation of the volume of the tumor (see Figure 5)
Because the mode of action of Stelfonta® is significantly different from other historical modes of cancer treatment, it may be unfamiliar to practitioners and owners. For this reason, it is extremely important that everyone involved is carefully prepared for the administration and monitoring of the treatment.
In particular, owners need to understand that the normal result of Stelfonta® injection is necrosis of the tumor, and this results in an open wound, which then heals by secondary intention.
Owners could be shocked if they are not prepared for the appearance of the wound during the normal course of treatment.
In Tabasco’s case, we sat down with the owners and looked at pictures and videos of actual treatments in other cases. We indicated that we should expect to see an open wound on Tabasco’s face, and that this may be uncomfortable or painful, and require analgesic support.
Also extremely importantly, injection of Stelfonta® can result in mast cell degranulation syndrome, which can cause severe symptoms and some risk of death if not prepared for, or managed correctly.
For this reason, a strict regimen of steroid and antihistamine administration must be followed before, during, and after the treatment.
After all this discussion, the owners indicated that they were comfortable with the plan, and we started our preparation.
Figure 3 shows the schedule for the oral medications to be given to manage the risk of degranulation syndrome. The owners were given a hard copy to fill out daily at home.
Next, the tumour was measured to calculate the tumour volume (see Figure 4), and therefore the Stelfonta
treatment volume. The Virbac website for Stelfonta has a useful calculator for this purpose.
In Tabasco’s case, the calculated tumor volume was 0.5 cm³, resulting in a Stelfonta® volume of 0.25 mLs.
We elected to use sedation for the administration of the Stelfonta®, due to the location of the tumor, particularly its proximity to the eye. Accidental injection into either the wrong site on the patient, or indeed into one of the staff, results in a very nasty injury which can be very painful and disfiguring.
We didn’t want to take that risk, and the owners agreed to a brief sedation for the procedure.
We sedated Tabasco with butorphanol 0.1 mg/kg + midazolam 0.1 mg/kg, followed by alfaxalone IV to effect. Sedation was stable and recovery uneventful.
The 0.25 mL of Stelfonta® was introduced into the tumor by entering through a single needle entry point, followed by distribution within the tumor with a fanning motion as shown in the diagram in Figure 5. The needle was then carefully withdrawn and firm pressure applied to the site for one minute to prevent leakage onto the surface and surrounding tissues. All staff wore gloves to prevent any contact with the skin.


After the injection, things started to happen very quickly!
Within 5 minutes, the nodule had changed appearance already—It became swollen and adopted a bruised, dark reddish grey color (see Figure 6)
We placed a simple adhesive dressing, which remained on for the next 3 days.
As well as the steroid and antihistamine medication above, we provided gabapentin 10 mg/kg to be given for analgesia at home.

Tabasco made an excellent recovery from the sedation and procedure, and the owners didn’t end up giving any gabapentin at home, as they saw no sign of pain at any time.
After 3 days, the owners removed the dressing, and this (Figure 8A ) was the appearance of the wound:
Obviously, had the owners been unprepared, this wound may have been concerning. As it was, with our preparatory discussions, it was much better than they had expected/feared, and the owners were very happy with the whole process.





8. A. At 4 days post injection. B. 6 days post injection C. 14 days post injection D. 6 weeks post injection.
Figure 8 is a sequence of pictures of the wound at various stages after the injection.
So, at the time of writing, the tumour is completely undetectable.
Because the tumor was not graded, and not exhaustively staged, we can’t tell whether the condition is cured—this is an important limitation of this mode of therapy.
It is a significant paradigm shift from the conventional approach, which would consist of grading and staging, full surgical excision with appropriate margins, followed by adjunctive systemic therapy if warranted.
That may indeed be a more reliable means of inducing a complete cure in a higher proportion of cases.
On the other hand, that would involve a very significant facial surgery, a prolonged surgical plane of anaesthesia, and much higher costs.
We would not claim that treatment with Stelfonta® is objectively superior in this case.
We would, however, claim that it was a simple, quick, and relatively affordable procedure which the dog tolerated extremely well, and that resulted in high owner satisfaction.
Each individual case must be considered on its own merits, and all precautions and preparations must be followed with extreme care.
Use of tigilanol tiglate (Stelfonta®) in this case was consistent with current label indications. The tumour was a single, cutaneous mast cell tumour with a calculated volume of 0.5 cm³ and a diameter well below the maximum recommended size of 3 cm and 10 cm³, respectively. No evidence of metastatic disease was identified on basic staging, and only one lesion was treated at a single treatment session.
Stelfonta® is licensed for non-metastatic cutaneous mast cell tumours at any body site and for subcutaneous mast cell tumours on the distal limbs (below the elbow or hock). It is not recommended for use in high-grade mast cell tumours, tumours with confirmed metastatic spread, or for subcutaneous tumours located on the trunk. Particular caution is advised when treating lesions in anatomically sensitive areas such as the face, especially in proximity to the eye, nasal opening or oral mucosa, and in brachycephalic breeds where post-treatment swelling may compromise the airway.
There are no specific breed restrictions for Stelfonta® use; however, caution is advised in very small dogs and in patients with significant concurrent disease, including hepatic or cardiac dysfunction, or a history of severe mast cell degranulation. The product is contraindicated in pregnant or lactating animals and should not be used concurrently with cytotoxic chemotherapy agents. As with all mast cell tumour treatments, incomplete staging limits the ability to determine long-term disease control or cure, and this represents an important limitation of this therapeutic approach.
Administration of Stelfonta® requires strict adherence to safety and handling protocols, including the use of personal protective equipment and careful injection technique, as accidental exposure may cause severe tissue injury. Owners must be fully informed that tumour necrosis and subsequent open wound formation are an expected and necessary part of treatment, and that the wound heals by secondary intention.
This case demonstrates that, when used within recommended guidelines and with appropriate patient selection and owner counselling, intralesional tigilanol tiglate can be a practical and well-tolerated alternative to surgery for selected cutaneous mast cell tumours located in cosmetically and functionally sensitive areas.

I recently bought 9 Vet Cookbooks to share with family, friends, and colleagues—an ideal gift for the people you love and admire. The stories and recipes inside beautifully showcase the diversity of our wonderful profession.
My own career has taken me from mixed practice in Western Sydney to small animal, zoo, and wildlife work in the Blue Mountains, and now I find myself involved in livestock welfare in the Central Tablelands. I still feel both useful and appreciated.
_Robert Johnson AM
The perfect gift for World Veterinary Day!
Saturday 25 April 2026—Celebrating diversity and equality
Never underestimate the value of your employees' sense of appreciation
Whether you’d like to show your appreciation to a staff member or the entire team, mark a work anniversary, welcome someone back, acknowledge an ‘above and beyond’ effort, or simply want to say thank you, this beautiful book makes a meaningful and lasting gesture of appreciation.
Sometimes, a small gesture speaks volumes.
Bulk discounts available.
cve.edu.au\vetcookbookii
A solution for our bee-allergic pets.
Dr Alex Moore BSc BVMS DipACVD
Veterinary Dermatology Clinic, Sydney
e. admin@vetdermclinic.com.au
t. 1800 832 838
C&T No. 6113

‘Minnie’, a 2-year-old female speyed cavoodle, presents to your GP clinic on a Friday afternoon in September. The weather is warm, the sun is shining and Minnie has been playing at her local, grassy oval with her humans. Minnie’s owners suddenly noticed her biting at her paw. Soon after she became lethargic, then vomited once… and again… before collapsing. They sprang into action and rushed Minnie straight to the vet clinic.
On presentation, Minnie has pale gums, she is responsive, but her mentation is dull and she is hypotensive. Upon closer inspection, you examine her forepaw and find…. a tiny bee stinger (it’s so small you almost miss it). You place an intravenous catheter, administer a fluid bolus and give a single dose of adrenaline. Thankfully, Minnie begins to perk up soon after… and you relax. What now…?
Did you know venom immunotherpay is offered by dermatologists to patients just like minnie?
Overview
Venom hypersensitivity is common amongst humans and companion animals. The most common culprits belong to the Hymenoptera family and include the honey bee ( Apis mellifera) and various wasps, commonly the Paper wasp (Polistes humilis) Adverse reactions to stinging insects are highly variable, but may include one, or a combination of dermatological, gastrointestinal, respiratory and/or cardiovascular clinical signs, depending on the species affected. This is a potentially life-threatening reaction whereby a patient response may become worse with subsequent insect stings. This can result in an anaphylactoid reaction, hypotension, bradycardia and even angioneurotic oedema (angioedema).
Venom immunotherapy (VIT) is the only preventative, long-term treatment for Hymenoptera hypersensitivity, apart from avoidance. This is indicated for individuals with severe and/or anaphylactoid reactions to stinging insects such as bees and wasps. VIT is commonly performed in people to reduce the severity of adverse reactions to Hymenoptera envenomation. It is less


commonly performed in dogs but has gained popularity and interest in recent times.
1. Confirm the patient is a good candidate for VIT VIT is only recommended for those dogs who present with severe reactions; it is not indicated for patients with mild, self-limiting, cutaneous clinical signs e.g. facial angioedema, local pain/pruritus, erythema etc. without systemic consequences. For these cases, vigilant owner monitoring and things like dog booties for physical protection from stinging insects are highly recommended.
2. Intradermal venom testing
Unfortunately, in many cases of venom anaphylaxis, a stinger is not found. This is also true for all wasp stings, as these insects do not leave a stinger behind and are thus able to sting repeatedly. For these cases, the veterinarian must rely on the pet owner’s history; physical examination findings and patient vitals upon presentation to the clinic will also aid diagnosis and guide treatment.
Bee and/or wasp allergy is diagnosed via intradermal (skin prick) venom testing. Venom testing is useful to confirm the diagnosis of Hymenoptera hypersensitivity and identify the causative venom/s.
Unfortunately, recent veterinary studies (Chan et al, 2023) have identified that serum IgE blood testing is not an accurate nor reliable diagnostic tool for venom allergies in dogs at the time of writing.
Intradermal testing is performed by a veterinary dermatologist under monitored sedation or general anaesthesia. Small, increasing quantities (and concentrations) of Hymenoptera venom are carefully injected into the dermis. A positive reaction is determined by the presence and degree of erythema, turgidity, size etc. (known as a ‘wheal and flare’ response). Honey bee and Paper wasp, both of which are found on the east and west coast of Australia, are the most commonly tested venom types in dogs. Intradermal testing is a day procedure, and patients are expected to be discharged that same afternoon.
3. Venom immunotherapy – Induction
Currently, there is no standardised VIT induction schedule in veterinary medicine that exists for dogs. Consequently, most veterinary dermatologists have adopted and modified protocols that have been designed for use in people.
VIT schedules generally consist of an induction phase and a maintenance phase. The induction phase can be performed using an ultra-rush protocol (completed in 1 day), a modified rush protocol (completed over 3 consecutive weeks) or using a conventional protocol (completed over a 5–6-month period). Many dermatologists utilise a rush VIT protocol, but this depends on the clinician’s preference.
y This is a 1 day procedure that takes place on 1 day a week, over 3 consecutive weeks under medical supervision in the dermatology clinic. Upon admission, patient vitals are recorded, an intravenous catheter is placed and chlorpheniramine is administered subcutaneously. Antihistamines are commonly utilised as a premedication in humans undergoing VIT and have proven efficacy and benefits in reducing the potential risk of adverse side effects.
y During the induction phase, increasing concentrations of bee and/or wasp venom are administered via subcutaneous injection. These injections are administered q 30-45 minutes and vitals are monitored and recorded, prior to each injection. If a patient is allergic to multiple venoms, 2 separate injections are administered in the left (bee) and right (wasp) dorsal cervical region. Injections are given over the course of 3 weeks. At the conclusion of VIT induction, the final dose of venom (100µg) is administered; this is the maximum dose given to VIT patients and is also the recommended maintenance dose.
Ongoing desensitisation therapy is recommended to maximise long term protection against potential future stings. The benefits of VIT include reduced incidence and severity of adverse reactions to Hymenoptera venom. In addition, rush VIT offers increased owner convenience, improved compliance and reduced time to protection against stinging insects via an accelerated induction protocol.
After completing rush VIT, the patient then commences maintenance VIT. This involves monthly administration of sub-cutaneous venom injections. Most VIT patients receive 100µg (1mL) venom q 4 weeks as a standard protocol; however, this varies slightly amongst dermatologists.
The recommended duration of VIT in people is ~3-5 years; however, high-risk individuals often remain on VIT life-long. Many owners elect to continue treatment for peace of mind and to reduce their own anxiety when taking their dog outside.
So next time you see a bee sting case, consider referring to your local veterinary dermatologist for venom desensitisation; it may just save a life.
C&T No. 6114
Richard Malik
CVE Valentine Charlton Consultant
e. Richard.Malik@sydney.edu.au
I think we are in an evidence free zone—although that will change.
If you treat FIP cats with long courses of antivirals—the great majority are cured, probably permanently.
I don’t think routine anaesthesia or procedures are problematic.
About immune suppression – I just don’t know. I feel more comfortable WATCHING – rather than trying to give preventive therapy.
Sally Coggins
BVSc (Hons I) MANZCVS (Medicine of Cats) PhD
Postdoctoral research fellow (Diseases and Treatment of Cats), Sydney Infectious Diseases Institute (Sydney ID)
The University of Sydney e. sally.coggins@sydney.edu.au
There is currently no evidence to suggest that immunosuppressive medications increase the risk of FIP recurrence; however, this is largely because high quality evidence in this area remains limited. That said, available clinical experience to date has been reassuring.
From an ongoing prospective European study, a 2024 ECVIM abstract documented cats undergoing primary antiviral treatment for FIP have received prednisolone, including immunosuppressive doses used for management of severe neurological disease, and have still achieved remission within standard treatment durations.
Similarly, cats with concurrent FIP and immune mediated haemolytic anaemia have been treated with prednisolone, and in some cases cyclosporine, without prolongation of antiviral therapy. In several cases, immunosuppressive therapy was continued after cessation of antivirals without subsequent recrudescence of FIP.
There are also individual reports of cats that developed unrelated diseases, such as lymphoma, following successful FIP treatment and subsequently underwent chemotherapy. Although these cats ultimately succumbed to their primary disease, there was no evidence of FIP recurrence, including at necropsy.
For immunosuppressive medications to meaningfully increase FIP risk, one of two mechanisms would need to exist:
1. Viral latency (as seen with herpes viruses or protozoal infections such as Toxoplasma gondii ), or
2. New exposure with de novo mutation to a pathogenic feline coronavirus variant.
With respect to viral persistence, in the small number of cats that recovered from FIP, later died of unrelated causes, and underwent necropsy, no evidence of ongoing viral persistence has been identified. While numbers remain very small, this makes latency appear less likely.
True recurrence of FIP following repeat exposure likewise appears to be uncommon, particularly in cats that have been off antiviral therapy and in remission for more than 3 months.
Given that tens of thousands of cats worldwide have now received antiviral treatment, and considering the ubiquitous circulation of enteric feline coronavirus, most FIP recovered cats will have been re-challenged with circulating FCoV by now. We are not seeing a mass of reports of FIP recurrence. In most cases where previously treated cats become unwell, another disease process is identified rather than recurrent FIP.
The prevailing hypothesis is that antiviral therapy suppresses viral replication sufficiently to allow the cat to mount a competent immune response and subsequently clear infection. If this is the case, cats that have achieved immune competence should be of no greater risk than the general cat population when exposed to immunosuppressive medications. Historically, FIP has not been considered a predictable risk when initiating drugs such as cyclosporine, in contrast to well recognised risks such as toxoplasmosis reactivation.
Although we still need more data in many areas to truly answer this question, my current stance is that cats with resolved FIP should, in most cases, be managed in the same way as any other cat unless new evidence emerges to suggest otherwise. If a cat has a legitimate indication for immunosuppressive therapy, these medications should not be withheld solely due to a history of FIP, although baseline Toxoplasma gondii serology and appropriate monitoring are recommended where relevant.

Online course available nationwide

Taronga’s Veterinary Professional Training in Wildlife Treatment and Care offers flexible online learning and a practical workshop to equip you with the skills in wildlife first aid, treatment and emergency care
• 20-hour online self-paced course (20 CPD points)
• Optional one-day practical workshop (12 CPD points)
• Designed for vets and vet nurses across Australia
• AVA & VNCA certified
• Supported by the NSW Department of Climate Change, Energy, the Environment and Water
Course fees start from just $200.
TODAY and start study when it suits you
taronga.org.au/vet-professional-training
Entitled to a CVE$300 voucher
Rebecca Tsai BVSC & Marcus Gunew BSc (Vet) FACVSc (Feline Medicine)
The Cat Clinic
Bonney Place318 Junction RoadClayfield TAS 4011
t. 07-3357 9902
e. admin@thecatclinic.com.au
e. mgunew@gmail.com
e. miso.misocute@gmail.com
C&T No. 6115
Marcy is an 8-year-old female spayed Domestic Short Hair cat living indoors in a single cat household. History from previous veterinary clinics indicated chronic sneezing and mucopurulent foul smelling nasal discharge predominantly from the left nasal cavity since February 2024.
Marcy was initially prescribed a 10-day course of doxycycline tablets, which resolved all clinical signs. However, there were then multiple recurrent episodes in May, June, September, and October 2024 respectively. These episodes were treated with repeat courses of doxycycline, steam therapy, and a recommendation for a feline respiratory PCR, and cryptococcus testing (LCAT) was made. The respiratory panel returned with a negative result for herpesvirus and calicivirus, and a positive result for Bordetella. LCAT was returned with a negative result. Further work up recommendations included radiography, rhinoscopy, and computed tomography.
Marcy initially presented to our clinic in April 2025 for chronic left sided nasal discharge. On cytology, there were large areas of degenerative neutrophils with intracellular bacteria. A nasal flush and culture was recommended, which was performed two weeks later. Advanced imaging was declined at the time. The nasal culture returned positive for Pseudomonas aeruginosa (sensitive to ceftazidime, enrofloxacin, gentamicin, and amikacin) and Pasteurella multocida (susceptible to amoxycillin/clavulanic acid, ceftazidime, enrofloxacin, doxycycline, TMPS, and cefovecin). A 2-week course of pradofloxacin was prescribed. Improvement was reported by the owner; however, mild discharge was still present. Therefore, a further 2-week course was prescribed, with the recommendation for computed tomography and nasal endoscopy if clinical signs remained refractory.
Marcy presented back to us on the 15th of July 2025 for a nasal endoscopy. Inflamed lymphoid tissue and mild haemorrhage was visualized via retroflexed nasopharyngeal endoscopy (Figure 1)

A left rostral nasal endoscopy was then performed, which allowed visualization and removal of a white fibrous foreign body using a 1mm endoscopic biopsy instrument (Figure 2)

2. Anterior rhinoscopy reveals fibrous material caught between inflamed turbinates and surrounded by some fresh blood
A nasal flush was performed to remove any residual debris. Post-procedure medications included subcutaneous injections of meloxicam and long-acting amoxicillin. Marcy was discharged the same day and
the owner reported her clinical signs had completely resolved the following day.

Atrophic rhinitis secondary to left nasal cavity foreign body , with secondary bacterial infection.
My best guess in the sequence of events was a foreign body entering the nasopharynx, by curled fabric entering the nasopharynx during swallowing, or entering the nasopharynx during vomiting. The fine wedge shape of the foreign body has then allowed it to work gradually forward in the nose over many months as the cat sneezed. I cannot imagine a scenario in which it entered the nasal cavity in a normograde fashion.
3. The foreign material after retrieval from the nasal passages of the cat
Dr Moira van Dorsselaer BVSc
The Cat Clinic Hobart
150 New Town Rd
New Town TAS 7008
e. moira@catvethobart.com.au
t. +613 6227 8000
C&T No. 6116
Inducing emesis in cats is often considered more challenging than in dogs, yet consistent success can be achieved with a structured approach. The following protocol has been effective in managing ingestion of linear foreign bodies and small objects such as hair ties or balloon ribbons.
Pre-presentation
Owners are instructed to feed their cat a full meal prior to arrival, ideally wet food. Having gastric contents appears critical for a reliable emetic response.
Induction protocol
– Sedative: Dexmedetomidine IM at 7 µg/kg (0.014 mL/ kg). Small-volume 0.3 mL insulin syringes (29G) are used to ensure precise dosing.
– Stimulation: Following injection, the cat is placed back in its carrier and gently rotated on a swivel stool for several minutes.
– Observation: The cat is then transferred to a quiet hospital cage for unobtrusive monitoring. Emesis typically occurs within 10–15 minutes.
Post-emesis care
– Reversal: Atipamezole at half the dexmedetomidine dose is administered once vomiting has occurred.
– Anti-nausea: Maropitant (1 mg/kg SC) is often given to prevent ongoing vomiting and nausea.
– Recovery: Most cats are ambulatory and suitable for discharge within one hour.
This protocol is efficient, welltolerated, and can be managed primarily by veterinary nurses, with veterinarians required only to prescribe and supervise the administration of medications.

Due to the current national shortage of apomorphine (emetic medication for dogs) in Australia, we’d be interested to hear what Vets are using?
Please reply to cve.marketing@sydney.edu.au .
Dr Alexander Teh
BVetBiol DVM MVetStud (Veterinary Pathology)
MVetClinStud DACVP
Specialist Anatomic Pathologist
Vetnostics NSW
Adjunct Associate Lecturer
Sydney School of Veterinary Science
The University of Sydney e. alexander.teh@sydney.edu.au
C&T No. 6117
History and Signalment
A 12-year-old Himalayan cat had hydronephrosis. During nephrectomy surgery, the kidney was noted to be very firm.
Histopathological Description
The kidney has marked and prominent hydronephrosis alongside a proliferation of dense fibrous tissue (Figure 1) Infiltrating and disrupting the renal cortex, is an invasive mass composed of neoplastic large and polygonal epithelial cells arranged in anastomosing trabeculae and cords associated with a scirrhous response (Figures 2-3). Neoplastic epithelial cells have infrequent to rare foci of individual keratinisation (Figure 2) and prominent intercellular spinous processes (Figure 3), typical of cells of squamous origin.
Primary squamous cell carcinomas occur very rarely in the kidneys and usually arise from the urothelium of the renal pelvis.1 This is because the urothelium retains the embryonic potential for differentiating into squamous epithelium.1 It has been theorised that chronic inflammation of the urothelium may initially cause hyperplasia of the transitional epithelium.2 With ongoing chronic inflammation, the accumulation of further mutations may result in squamous metaplasia of the transitional epithelium, progressing to in situ carcinoma, and finally invasive squamous cell carcinoma.2 Alternatively, it is also theorised that renal squamous cell carcinomas may arise from transformation of urothelial carcinomas.2
A similar case of unilateral renal squamous cell carcinoma arising from the renal pelvis with associated hydronephrosis in a cat has also been previously

Figure 1. Low power photomicrograph of the kidney showing marked hydronephrosis and effacement of the medulla towards the right of the dilated renal pelvis by abundant amounts of dense fibrous tissue
reported.2 This case also featured prominent omental carcinomatosis.2 In humans, renal squamous cell carcinoma is also considered to be a rare renal neoplasm, and similarly commonly presents with concurrent hydronephrosis.2
The literature on Renal Squamous Cell Carcinoma (SCC) in cats is very limited, reflecting the rarity of this tumour type in the feline kidney.
There is at least one documented case of renal SCC in a cat presenting with extensive abdominal carcinomatosis but no confirmed distant metastases on ultrasonography or exploratory surgery.3 This is reported as the first known case of SCC originating from the renal pelvis in a cat.
Chronic inflammation and urothelial irritation (such as from nephrolithiasis) are believed to contribute to metaplastic changes leading to SCC development, similar to processes described in humans and other animals.

Figure 2. Anastomosing trabeculae and cords of invasive neoplastic epithelial cells are present within the cortex associated with a dense and scirrhous fibrous reaction towards the left of the photomicrograph. Black arrows show infrequent to rare foci of individual cell keratinisation.
Prognosis for SCC in this location is poor due to advanced tumour stage and renal damage at diagnosis, with limited treatment success reported.
More commonly reported than SCC is renal transitional cell carcinoma (TCC) in cats, which is distinct but sometimes shows overlapping features or metaplasia. Renal TCC is also rare but more documented, and cases have demonstrated highly aggressive behaviour with metastases to multiple organs including lungs, skeletal muscle, and notably ocular metastasis in one case.4 The ocular metastatic case describes a young cat that presented with blindness due to ocular metastases before renal abnormalities were detected. Postmortem examination confirmed renal TCC with metastases to both eyes, lungs, and skeletal muscle. This report is the first of renal TCC with ocular metastasis in a cat.
While ocular metastases of carcinomas are uncommon in cats overall, when they occur, they are often from tumours with high metastatic potential such as TCC, lymphoma, or other aggressive carcinomas. The spread to the eye usually occurs haematogenously, affecting the choroid and retina due to high vascularity and vascular tortusosity.
Other feline squamous cell carcinomas are mostly reported in oral or cutaneous sites rather than renal, and metastatic behaviour varies with location and tumour aggressiveness.

Figure 3. High power photomicrograph of the neoplastic epithelial cells. The epithelial cells are polygonal and large with well-defined cell borders, large amounts of eosinophilic cytoplasm, a round to oval nucleus with coarse chromatin and sometimes a prominent basophilic nucleolus. Green arrow shows prominent intercellular spinous processes, typical of cells of squamous origin.
The paper Renal Crest Proliferative Lesions in Cats with Chronic Kidney Disease by White, Canfield, Malik et al. primarily focuses on proliferative epithelial lesions in the renal crest associated with chronic kidney disease (CKD). The findings describe the pathological background of renal carcinomas, including squamous cell carcinoma (SCC), in feline kidneys.
Key Points from this study include:
– Proliferative lesions in the renal crest, including hyperplasia and dysplasia of collecting duct epithelium and urothelium, are common in cats with CKD. These lesions form a continuum from benign hyperplasia to neoplasia (including carcinomas) of urothelium or collecting ducts in the renal crest
– Histologically, some of the carcinomas observed had features consistent with dysplasia and invasive growth with desmoplastic responses. Immunolabelling did not definitively distinguish tubular from urothelial origin, so these lesions were broadly classified as renal crest carcinomas
– Chronic inflammation and fibrosis were present alongside epithelial proliferation, supporting a link between chronic renal injury and the development of proliferative and neoplastic lesions. This suggests a pathophysiological pathway wherein persistent CKDrelated injury triggers epithelial proliferation leading to dysplasia and potentially carcinoma, including squamous metaplasia and transformation seen in renal SCC cases
The paper’s broader implications support the concept seen in rare renal SCC feline cases that chronic irritation or injury (such as from hypoxia), such as that from CKD or urinary tract inflammation, may predispose to malignant transformation in the renal pelvis or crest.
1. Meuten, D. J. (Ed.). (2017). Tumors in domestic animals (Fifth edition.). John Wiley & Sons Inc.
2. Gómez Selgas, A., Scase, T. J., & Foale, R. D. (2014). Unilateral squamous cell carcinoma of the renal pelvis with hydronephrosis in a cat. Journal of feline medicine and surgery 16(2), 183–188. https://doi.org/10.1177/1098612X13495866
3. Gómez Selgas A, Scase TJ, Foale RD. Unilateral squamous cell carcinoma of the renal pelvis with hydronephrosis in a cat. J Feline Med Surg. 2014 Feb;16(2):183-8. doi: 10.1177/1098612X13495866. Epub 2013 Jul 1. PMID: 23817013; PMCID: PMC11383137.
4. Grader I, Southard TL, Neaderland MH. Renal transitional cell carcinoma with bilateral ocular metastasis in a cat. JFMS Open Rep. 2016 Jul 14;2(2):2055116916659516. doi: 10.1177/2055116916659516. PMID: 28491432; PMCID: PMC5362896.
5. Joanna D. White, Katrina L. Bosward, Jacqueline M. Norris, Richard Malik, Scott A. Lindsay, Paul J. Canfield. Renal Crest Proliferative Lesions in Cats with Chronic Kidney Disease, Journal of Comparative Pathology , Volume 187,2021,P 52-62, ISSN 0021-9975, https://doi.org/10.1016/j.jcpa.2021.07.002
Dr Avril Lim
BVSc (Hons) MVS MANZCVS DACVIM (SAIM) GDip Entr
Founder, Animal Lifesource & Smart Vet Hospital, Australia
Registered Veterinary Specialist, Board Certified in Small Animal Internal Medicine
e. info@smartvethospital.com.au
C&T No. 6118
Introduction
Veterinary transfusion medicine has become an indispensable part of modern practice. Advances in emergency and critical care, internal medicine, oncology, and surgery mean that blood transfusions are increasingly required to save the lives of small animal patients. Yet despite this need, Australia remains underserved by reliable, readily available blood products.
At present, many referral centres and general practices face the daunting reality of sourcing donors at the eleventh hour, often from the owners of critically ill patients themselves. This not only places immense stress on families during a vulnerable time, but also hampers our ability as veterinarians to provide optimal, timely care.
Through Animal Lifesource, my mission is to change this. By developing a sustainable, centralised veterinary blood banking system and raising awareness within the general practice (GP) community, we can ensure safe and efficient access to blood products across Australia. This article outlines why this matters, the costs and commitments involved, and how every GP can play a role in building a future that mirrors the success of Red Cross Lifeblood for humans.
Unlike human medicine, where national blood services ensure robust availability, veterinary practices in Australia rely on fragmented, ad hoc donor programs. Referral hospitals may keep a handful of donor animals,
often staff-owned pets or cooperative volunteers, but maintaining a reliable pool is difficult.
The reality is sobering:
– Emergency demand is unpredictable. Snake envenomation, road trauma, surgical haemorrhage, and immune mediated diseases can present suddenly. Without prepared blood products, clinicians scramble.
– Owners are often asked to find donors. Families facing their pet’s critical illness are simultaneously burdened with sourcing a suitable dog or cat, matching blood type, and arranging testing.
– Turnaround time is limited. Without prescreened donors and processed products on the shelf, every minute lost in preparation worsens the patient’s prognosis.
It is not uncommon for clinicians to feel powerless when no donor is available at the moment it is most needed. This is not a failing of individual veterinarians, but rather of the system we currently work within.
Some practitioners may wonder why donor prescreening is such a significant hurdle. The answer lies in both safety and quality control.
To ensure transfusion safety, each donor must undergo comprehensive health checks and infectious disease screening. This includes:
– Physical examination
– Complete blood count and biochemistry
– Blood typing
– Bloodborne infectious disease testing
The cost of these tests and assessments is not trivial. On average, prescreening a single donor costs around $600. This is an upfront investment, but one that ensures not only the safety of the recipient, but also the wellbeing of the donor.
Each donor represents a highly valuable resource, a carefully selected, comprehensively screened, and deeply cared for individual who may contribute to saving dozens of lives over their service period.
Relying on unscreened, last-minute donors carries significant consequences for both patients and veterinary teams.
– Transmission of infectious disease into an already immunocompromised patient
– Delayed care, as emergency staff scramble to find a donor and perform minimum testing
– Increased family distress, as owners are asked to solve logistical problems in the midst of crisis
– Inefficient use of donations, when whole blood is used because packed red cells or plasma are not prepared in advance
These challenges compound in high demand seasons such as summer, when snake envenomations spike across much of Australia. Every hour of delay can mean the difference between survival and loss.
Whole blood has long been the mainstay of veterinary transfusion. However, modern transfusion medicine increasingly recognises the value of component therapy. By processing whole blood into packed red cells and plasma, we can:
– Tailor treatment to the patient’s needs (for example, red cells for anaemia, plasma for coagulopathy)
– Reduce wastage by ensuring each donation benefits multiple patients
– Extend shelf life, with red cells preserved for weeks and plasma for years when frozen
At Animal Lifesource, I currently provide whole blood processing services to help hospitals prepare these components in advance. This allows for more efficient, evidence-based care. Hospitals can stock products ahead of anticipated demand and reduce the urgency of sourcing last minute donors.

Here lies the key message for the general practitioner: a few minutes of conversation can change lives
Every day, GPs see healthy, young, well cared for dogs and cats, precisely the kind of animals who make excellent donors. By raising the idea with owners during routine consultations, wellness checks, or vaccinations, GPs can help grow the donor pool dramatically.
– Between 1- and 8-years-old
– Over 25 kg and lean in body condition
– Friendly temperament and comfortable in clinical environments
– Up to date on vaccinations and parasite prevention
– Not on long term medication
Ideal Feline Donors
– Between 1- and 8-years-old
– Over 4 kg and lean body condition
– Calm temperament and tolerant of gentle restraint or sedation
– Up-to-date on vaccinations and parasite prevention
– Not on long term medication
For many owners, learning that their pet could save another animal’s life is profoundly meaningful. Donating blood is not only altruistic but also builds a sense of
community within the veterinary profession and the pet owning public.
By simply planting the seed of this idea, GPs empower Animal Lifesource to connect with willing families and build a sustainable, prescreened donor program.
In human medicine, the success of centralised blood banking is self evident. Australians expect that if they or a loved one require a transfusion, safe and compatible products will be available without delay. This expectation exists because of decades of investment, coordination, and national commitment.
Veterinary medicine should aspire to the same standard. By working together to create a coordinated network of veterinary blood donors and component therapy, we can:
– Reduce shortages and prevent wastage
– Provide consistency of product quality and safety
– Increase equity of access for suburban clinics and regional hospitals
The parallels with Red Cross Lifeblood are striking. What we lack is not willpower, but infrastructure and awareness.
Veterinarians often speak of the profession’s commitment to One Health, recognising the interconnection of human, animal, and environmental wellbeing. Blood banking embodies this ethos.

Figure 2. Blood separated into packed red cells and plasma
Just as human patients deserve access to safe transfusions, so too do our animal patients. As clinicians, we have an ethical responsibility to reduce preventable suffering. Asking owners to source a donor in crisis is not just logistically challenging, it is ethically troubling when we know there is a better way.
By investing in donor screening, blood processing, and coordinated blood banking systems, we align veterinary medicine with global standards and uphold the profession’s duty of care.
Some GPs may hesitate to raise donor programs with clients, citing concerns such as:
– ‘Owners will not be interested.’
In reality, many owners are enthusiastic about the idea of their pet saving lives. When presented as an altruistic opportunity, the response is often positive.
– ‘It takes too much time.’
A brief mention during annual health checks is sufficient. The detailed discussion and screening process is handled by Animal Lifesource.
– ‘Is it safe for the donor?’
Yes. When conducted in accordance with established guidelines, blood donation is safe for healthy dogs and cats. We adhere to the 2021 International Society of Feline Medicine (ISFM) Consensus Guidelines for feline blood collection, using conservative donor selection and additional safeguards to minimise risk. All donors are privately owned pets who donate infrequently and only when clinically appropriate, with donor welfare as the priority. Further ethical considerations are detailed in the ISFM consensus statement.
– ‘What if I do not know enough about transfusion medicine?’
GPs are not expected to manage transfusion logistics. Their role is simply to connect owners of suitable pets with Animal Lifesource, where the process is fully managed.
The road toward a centralised veterinary blood banking system will not be quick or easy. But every journey begins with a single step.
For GPs, that step is simple: talk to owners of healthy dogs and cats about becoming blood donors.
For referral centres and emergency hospitals, the next step is to embrace component therapy and collaborate in building a reliable inventory.
For the broader profession, the goal is clear: reduce blood wastage, improve access across the country, and ensure that no patient misses out on a lifesaving transfusion because of shortages.
This is not a dream. It is an achievable, tangible future, but only if we work together.


Patient care is important from the moment they come into the clinic to the time they leave. When drawing up a medication, we check the drug, double check the dose and label the syringe with the appropriate sticker to indicate who the drug is for and what is in the syringe.
So why would we not want the same safety check with our infusion lines?
Enhancing Safety and Efficiency in Veterinary Infusion Therapy: Introducing Colour-Coded Minimum Volume Tubes
Our patients rely on us to give them the best care possible. They, and their owners, trust that what we use to deliver their treatments will not cause them any harm. In the fast-paced environment of veterinary hospitals, clarity and precision in drug administration are essential—not just for outcomes, but for peace of mind. The introduction of colour-coded minimum volume IV tubing marks a meaningful step forward in infusion therapy—designed to support clinicians in delivering safe, efficient, and error-reduced care.
Veterinary teams often manage multiple high-potency drugs simultaneously. Colour-coded tubing enables clear drug assignment and rapid identification at a glance, helping reduce the risk of medication errors and enhancing workflow efficiency during critical procedures.
In addition to offering three vibrant colours (BLUE, MAGENTA , and GREEN), Perfusor™ tubing retains these vital, yet sometimes overlooked characteristics:
1. Low priming volume (≤1.27 mLs) minimizes drug waste and ensures rapid therapy initiation.
2. Pressure resistance up to 2 bar supports reliable performance with syringe drivers, even in demanding clinical scenarios.
3. Luer-Lock fittings ensure secure connections across all standard syringe driver systems.
Made from polyethylene (PE), the Perfusor™ Line is free from PVC, DEHP, and latex, making it a safer choice for sensitive animal patients. Its low sorbing properties and kink-resistant design further support consistent drug delivery—because every patient deserves the best we can offer.
Available in two lengths (150 cm and 200 cm), the Perfusor™ Line adapts to varied clinical setups. Whether managing anaesthesia, critical care, or post-operative recovery, veterinary professionals can rely on its excellent start-up characteristics and minimal residual volume to maintain therapeutic precision.
In veterinary medicine, where precision and patient safety are paramount, the materials used in infusion therapy can have a profound impact—especially in high-risk procedures involving neonates, critical care, and long-duration infusions. One such material under global scrutiny is DEHP (Di(2-ethylhexyl) phthalate), a plasticiser commonly used in PVC-based medical devices.
DEHP has been classified by the European Union as a Substance of Very High Concern, specifically toxic to reproduction. Studies have shown that DEHP can leach from PVC tubing during medical procedures, potentially affecting the testes, liver, and kidneys in animal models, and is suspected to impair fertility in humans—particularly in critically ill male neonates, unborn children of pregnant women, and nursing infants exposed to high levels of DEHP. [DEHP-Free A4]
Global health authorities have responded decisively:
– EU: Banned DEHP in toys and baby articles since 2007; mandatory labelling for medical devices since 2010. [DEHP-Free A4]
– USA (FDA): Issued public health notifications and precautionary guidelines to reduce DEHP exposure. [DEHPFree A4]
– Australia: Declared products with >1% DEHP unsafe for children; DEHP in medical devices can reach up to 40%. [DEHP-Free A4]
– Canada: Requires manufacturers to disclose DEHP content exceeding 0.1%. [DEHP-Free A4]
Although not mandated in Australia, B. Braun has proactively converted its entire infusion therapy portfolio to DEHP-free materials—with no change in part numbers or pricing. This reflects a deep commitment to patient safety, environmental responsibility, and the professionals who care for animals every day. [DEHP-Free A4]
References:
1. EU directive 67/548/EEC
2. Directive 93/42/EEC and its amendment 2007/47/EG
3. FDA Public Health Notification 12/07/2002
4. The Commonwealth of Australia Consumer protection Notice No. 11 of 2011
5. NICNAS - Existing chemicals information sheet 01-2010
6. Health Canada notice 08-111801-312, May 2008
7. Safety Assessment of DEHP, released from PVC Medical Devices FDA, 2001
8. SCENIHR - “Opinion on the safety of medical devices containing DEHP-plasticised PVC or other plasticisers on neonates and other groups possibly at risk”, Feb 2008
9. Umwelt bundesamt (Germany) “Phthalates - Useful plasticisers with undesired properties”, Feb 2007
10. K. Ruzidckova, M. Cobbing, M. Rossi, T. Belazzi, “Preventing Harm from Phthalates, Avoiding PVC in Hospitals”, Health Care without Harm, June 2004
Theodora Kletsas
Mascott Veterinary Hospital
3/220 King St Mascott NSW
w. mascotvet.com.au
t. 93173337
C&T No. 6119

Pandora, a 1-year-old female spayed Domestic shorthair cat presented for routine health examination and vaccination in January 2024. She had a soft tissue swelling at the level of RUPM3 (108) and the tooth was not visible.
PM2 (107) adjacent the affected area had calculus present. All other teeth were normal and had grade 0 or 1 dental score (i.e. no periodontal disease and no calculus or plaque). Local lymph nodes were not abnormal and no other abnormal findings were noted at that examination. Radiographs were recommended but the owner declined because Pandora had not had any evidence of ill health.
Pandora’s owner returned for radiographs two months later. Radiographs were indicative of right maxillary dentigerous cyst. Biopsy, histopathology and cyst excision was recommended.




Discussion
Dentigerous cysts develop when a tooth fails to erupt normally and are more commonly associated with permanent teeth. In young cats, this typically occurs due to impacted or embedded teeth often involving the canine teeth or premolars.
The cyst forms from enamel epithelium surrounding the crown of the unerupted tooth. As fluid accumulates, the cyst expands, potentially causing damage to surrounding structures.
Missing or unerupted teeth beyond the normal eruption period as well as possible facial swelling or asymmetry in advanced cases may be seen. In advanced cases, yellow viscous fluid may be yielded on fine needle aspiration.
Dental radiographs are crucial for identifying unerupted teeth and associated cystic structures. Dentigerous cysts are centred on an unerupted tooth with a thin layer of bone surrounding the tooth.
Definitive diagnosis requires histological examination. Histopathology will also evaluate whether the cyst has associated neoplastic tissue.
Characteristic features include a cyst wall lined by stratified squamous epithelium attached to the cementoenamel junction of the affected tooth.
Take home point for nervous GP clinicians like me
Dentigerous cysts and feline inductive odontogenic tumours are more likely to be seen in young animals. Odontogenic cysts are more subtle and more likely to be incidental findings vs cystic tumours that tend to display more swelling and tooth displacement. Radiographically cysts are more often within well defined, regular borders. Cystic tumours are more consistently multilocular and expansile.
Treatment is the extraction of the unerupted tooth and associated cystic lining. The excised tissue should be sent for histopathology to rule out neoplasia.
References
Gioso MA, Carvalho VGG. Maxillary Dentigerous Cyst in a Cat. Journal of Veterinary Dentistry. 2003;20(1):28-30
Hoffman S. Abnormal Tooth Eruption in a Cat. Journal of Veterinary Dentistry. 2008;25(2):118-122
Poulet FM, Valentine BA, Summers BA. A survey of epithelial odontogenic tumors and cysts in dogs and cats. Vet Pathol. 1992 Sep;29(5):369-80
D’Astous J. An overview of dentigerous cysts in dogs and cats. Can Vet J 2011 Aug;52(8):905-7

Figure 1. Suspected mechanism of increased urinary Cystatin B in acute kidney injury. Figure source: DOI: 10.1016/j.cvsm.2016.06.011
Acute kidney injury (AKI) can occur before changes are detected in traditional renal biomarkers such as creatinine. Functional markers like creatinine and symmetric dimethylarginine (SDMA) reflect glomerular filtration rate (GFR) and may not identify early renal tubular injury. Novel biomarkers that detect cellular injury may therefore allow earlier diagnosis and intervention.
Urinary cystatin B is an intracellular protein released from damaged renal tubular cells and has been shown to increase rapidly following tubular injury. This biomarker may enable earlier identification of AKI compared with conventional renal markers.
A prospective study currently underway at MediPaws Veterinary Specialist Centre is evaluating urinary cystatin B concentrations in dogs undergoing Tibial Plateau Leveling Osteotomy (TPLO) surgery. TPLO provides a useful clinical model due to the relatively uniform patient population and standardised anaesthetic and surgical protocols.
The study aims to recruit 60 dogs and assess perioperative renal biomarkers before surgery and at multiple time points post-operatively to determine the incidence of subclinical AKI.
Access the full article, including methodology, references and client information here
Contact t 1800 678 387
e. reception@medipaws.com.au
To discuss the study in detail please contact Dennis Woerde BVSc (Hons1) DACVIM (SAIM)
Specialist in Internal Medicine
e. dennis.woerde@medipaws.com.au
iCatCare Veterinary Society, formerly the International Society of Feline Medicine (ISFM), partner with the CVE to deliver the Feline Medicine Distance Education course. Due to its comprehensive content, it is spread over 2 years to allow the busy practitioner to fully engage with the course whilst maintaining life and work balance.
cve.edu.au/feline-medicine-de
Linda Ryan
BSc (Hons) VTS (Behaviour and Oncology)
DipAVN (Medical) KPACTP
RVN CCABC
C&T No. 6120
Behaviour problems in cats are frequently encountered in veterinary practice, yet they are often complex, multifactorial and closely linked to medical, environmental and emotional factors.

In this article, veterinary nurse and clinical animal behaviourist Linda Ryan explores how training and behaviour modification can be integrated into clinical case management to improve outcomes for feline patients and the people who care for them.

Read the full article here
This issue includes articles covering the relationship between gallbladder changes and infection, the identification of cats with osteoarthritis, the treatment of hyperkalaemia associated with urethral obstruction and ocular changes linked with anaemia and thrombocytopenia.
5 articles including Implementation of a prospective inclinic validated Feline Osteoarthritis Checklist

cve.edu.au/rr-march-26
Specialist in Veterinary Diagnostic Imaging Swedish University of Agricultural Sciences
Uppsala Sweden
e. charles.ley@slu.se
C&T No. 6121
An 8-month-old female desexed Labrador retriever cross presented for a 4–6-week duration of left forelimb lameness.
On clinical exam, there was mild pain on manipulation of both shoulder joints.


The International Cat Care Veterinary Society (formerly ISFM) is the veterinary membership division of pioneering cat welfare charity International Cat Care (iCatCare), bringing together a global community of veterinary professionals dedicated to improving the lives of cats worldwide. Trusted by vets and nurses, it
Q. What is your radiological diagnosis?
provides professional development and CPD through access to expert knowledge resources, including the Journal of Feline Medicine and Surgery (JFMS). The iCatCare website is also a trusted resource of information and guidance for veterinary professionals, cat owners and caregivers

Authors’ views are not necessarily those of the
Dr Moira van Dorsselaer BVSc
The Cat Clinic Hobart
150 New Town Rd
New Town TAS 7008
e. moira@catvethobart.com.au
t. +613 6227 8000
C&T No. 6122
Raymond is a Male Neutered Domestic Shorthair cat who was found as a stray kitten at 4-5 weeks-of-age. Since then he has lived indoors with a companion cat.
He presented at 9-months-of-age with what the owner thought was an abscess from the other cat with whom it play fights.





The
cve.edu.au Email your answer to us at cve.marketing@sydney.edu.au

First quantitative macroarray IgE test specifically for animals
Only 0.5ml of serum required for testing
Fully automated process, higher level of standardisation
Over 200 allergen extracts and molecular components



Allergic disease remains one of the most common challenges seen in veterinary practice. PAX® (Pet Allergy Xplorer), now available through Nextmune Laboratories Aus, represents a new generation of serum allergy testing designed to provide more precise identification of allergen sensitisation.
PAX combines traditional allergen extracts with defined molecular allergen components, allowing veterinarians to assess IgE responses at a more detailed level. This approach improves standardisation, reduces cross-reactivity, and supports more targeted clinical decision-making. The panel evaluates more than 200 environmental and food allergens using only a small serum sample.
While most commonly utilised in small animal practice, PAX is also available for equine patients where investigation of allergic disease is indicated.

Sample submission

Clinics can request a PAX submission kit from Nextmune Laboratories Australia. Once serum has been collected, the completed submission form and sample can be returned using the provided packaging, making the process straightforward for both general practice and referral settings. Results will be made

The PAX® results are clearly set out, easy to interpret and include the following information:
Summary of detectable sensitisations
interpretation summary and treatment recommendation
Detailed results per extract and components
quantitative multiplex macroarray specifically designed for companion animals
Over 200 allergens included = lower testing cost per allergen
Fully automated process = higher level of standardisation (same result if tested multiple times)
With cross-reactive carbohydrate determinants (CCD) blocking and 2 blocking efficiency detectors
Only 0.5 ml of serum is needed
Expected increase in serological test sensitivity due to a higher concentration of molecular allergens
Identification of ”primary” sensitising allergens
Identification of allergen cross-reactivities
Continuous support and advice with our vet allergy experts

Detailed interpretation with information about allergenicity and relevance, time of the year, possible cross-reactivities and treatment indication for each allergen.

Nextview is a portal where you can manage all your allergy samples, PAX results, immunotherapy orders, reorders and much more.
Complete clinic management
Filter by patient name, client name or

Oversight of order progress from initial order to invoicing

Complete order history for all patients Easy-tointerpret results
Reply to C&T No. 6107 Issue 321, Dec 2025
C&T No. 6123
Clifton Hill Vet Clinic
470 Wellington St
Clifton Hill VIC 3068
e. jandk@jsandford.com.au
t. 03 9489 4055
I had to smile again when I read the above. This is the second time in my professional life that I think I have independently invented a useful item or procedure (see my as yet unpublished item on use of twisted wires to unblock FUS cases). In this case it is the use of Allis Tissue Forceps to gauge how much and what shape of skin to remove in the case of entropion. I recall using this technique in the late 60’s –early 70’s when we vets encountered many more entropion cases compared to these days (especially Poodles).
It is an excellent technique in that any ‘Jo Blo’ can do it well because it is initially ‘adjustable’. I can remember a couple of times doing it with a little too much crimping force initially and then readjusting it and wondering if they would breakdown (luckily, they did not!). One can lightly crimp, (perhaps a little less skin than the required amount) so the skin ‘stands up’ as per photo 6 in Kim’s article (see below) and then adjust it if not seen as the right length or width and when satisfied, crimp much more tightly. When finally very tightly crimped, it makes it easier to use (curved) scissors without the addition of even normal toothed tissue forceps (they get in the way) Then by using the opposite thumb and fore finger, a little distal to the end of the ridge to stop that end flattening out, one can excise precisely, the required amount without the peaked skin flattening out annoyingly.

Robin Stanley BVSc(Hons) MANZCVSc(Small Animal Surgery) FANZCVSc(Ophthalmology)
Veterinary Eye Specialist

w. animaleyecare.com.au
Thankyou Drs Kendall and Smith for contributing the Feline Entropion surgery article.
We are seeing more cases of entropion in cats. This seems to be most common in older cats. In really old cats that are an anaesthetic risk, I love to use collagen filler under twilight anaesthesia for these cases.
With all entropion cases it is important to rollout the lower eyelid; I personally find using the Jager lid plate and a scalpel works best for me.
It is ALSO important to close the lateral canthus down. We do this on both eyes even if the fellow eye is not rolling in. In a paper that Animal Eye Care published, we showed the risk of recurrence in the affected eye and the risk of entropion developing in the normal fellow eye.
White, J.S., Grundon, R.A., Hardman, C., O’Reilly, A. and Stanley, R.G. (2012), Surgical management and outcome of lower eyelid entropion in 124 cats. Veterinary Ophthalmology, 15: 231-235. https://doi.org/10.1111/ j.1463-5224.2011.00974.x
Comment on C&T No. 6097 Issue 321, Dec 2025
Robin Stanley BVSc(Hons) MANZCVSc(Small Animal Surgery) FANZCVSc(Ophthalmology)
Veterinary Eye Specialist
w. animaleyecare.com.au
C&T No. 6124
I am very pleased that Dr van Dorsselar was able to save this kitten’s eyes. A deserving winner of the C&T prize.
Like Dr van Dorsselar, I too find Cidofovir to be the best topical anti-viral preparation. The downside is that it is expensive and needs to be compounded.
Time is very important here; in these young kittens the corneas can literally melt, and we regularly see symblepharon forming, and in some cases with perforated corneas with iris prolapse. I have found that the human Aciclovir 3% ointment to be very effective in these cases seen in kittens. It is readily available from human pharmacies and unlike the Cidofovir is relatively cheap at AU$20.99 as of December 2025. Please note that that the human Aciclovir eye ointment does not seem to be that effective for ulcers in adult cats.
I use this Aciclovir eye ointment 4 to 6 times daily in these acute infections. They usually respond.
I completely agree with Dr van Dorsselar about using high quality artificial tears such as Blink Intensive Tears or Hylo-Forte.

"I was very surprised to get this award, I was just doing my job. I really do enjoy helping vets learn about eyes in practice, and it is really special to see when the lightbulb clicks on when something connects.
One of our clinic’s golden rules is to use these high-quality artificial tears twice daily for 6 weeks after any feline corneal and or conjunctival disease. We seem to have far fewer problems with this protocol.
If you are interested in Ophthalmic surgery, please consider the Ophthalmic Surgery course that I run.

Video: Gizmo 24 hours after hospitalization and pain relief etc started—you can see despite how horrible her eyes look she is so happy cve.edu.au/gizmo
Ophthalmology Distance Education tutor since 1992 who was recognised in this year's Australia Day Honours with a Member of the Order of Australia (AM) in the General Division for ‘significant service to veterinary ophthalmology, and to tertiary and vocational education’.
Drs Robin Stanley & Jane Whitley
Practical Ophthalmology TimeOnline 16 Mar - 12 Apr 2026 | 10 CPD Points
Ophthalmic Surgery TimeOnline 1 - 28 Jun 2026 | 10 CPD points
Drs Robin Stanley & Matthew Sanders
Ophthalmology Distance Education 1 Feb - 30 Nov 2027 | 334 CPD points

BVetBiol DVM MVetStud (Veterinary Pathology)
MVetClinStud DACVP
Specialist Anatomic Pathologist
Vetnostics NSW
Adjunct Associate Lecturer
Sydney School of Veterinary Science
The University of Sydney e. alexander.teh@sydney.edu.au
*Corresponding author
C&T. No. 6125
Clinical History
This is a hand-raised juvenile Eastern grey kangaroo with diarrhoea and dependent oedema. Samples of intestine were collected post-mortem.
Histopathological Description
The intestinal mucosa and lamina propria are disrupted by many large, giant schizonts (Figure 1) containing abundant crescent-shaped merozoites (Figure 2). There are numerous intraepithelial gametocytes within the mucosa (Figure 3). Other inflammatory changes present included villous blunting, regions of epithelial injury and erosion, and infiltration of the mucosa by granulocytes and mononuclear cells.

Figure 1. Low power photomicrograph of the intestine showing giant intramucosal schizonts (black arrows).
Dr Jovene Lee BSc DVM
Veterinary Diagnostician
Gribbles Veterinary Pathology, South Australia
Coccidiosis in Macropods BACKGROUND
Coccidia are obligate intracellular, host-specific protozoa with a worldwide distribution. Coccidiosis is an important disease of captive marsupials and are more frequently seen in juvenile macropods.
In Australian wildlife, Eimeria spp. is the most common coccidian infection (Wildlife Health Australia, 2025). The prevalence figures for Eimeria spp. in Australian wildlife range from 24% (Yang et al 2012) to 92% (Vermulen 2022) in various macropod species. Note that normal healthy wildlife may be carriers as oocysts are often found in faeces of healthy wildlife. Free-range wildlife is theorised to have developed immunity to coccidia as adults, as they are likely to be exposed to it as juveniles. This is why coccidiosis is more commonly seen in juvenile captive wildlife compared to free-range wildlife.
Eastern grey kangaroos are more prone to coccidiosis compared to other species of kangaroos (Spielman n.d.) which often present with high mortality rates in handreared juveniles (Ladds 2009). Environmental factors are associated with outbreaks in captivity. These are often related to stressful situations such as weaning, transportation and diet changes. Other factors such as overcrowding and damp conditions may also contribute indirectly by providing an optimal condition for coccidial survival and sporulation.
Coccidia can complete their entire lifecycle within one host.
Coccidia oocysts are shed in their faeces. The oocysts will sporulate under favourable conditions (e.g. oxygen,

Figure 2. High power photomicrograph of the intramucosal schizonts containing abundant crescent-shaped merozoites.
Figure 3. High power photomicrograph of the intestinal mucosa showing numerous intraepithelial gametocytes.
humidity and temperature). Once sporulated, the oocysts become sporulated oocysts (sporocysts) within several days. A susceptible host then ingests the sporulated oocysts (this is the infective stage).
Within the intestinal tract, the sporozoites are released (excystation) from the oocysts and invade the intestinal mucosa. The sporozoites develop within intestinal cells into multinucleated schizonts (also known as meronts). The schizonts then develop asexually into an infective body (merozoite), which invade new intestinal cells and repeat the process. This is the asexual portion of the coccidia lifecycle.
Depending on the species, the merozoites will develop into macrogametocytes (female) or microgametocytes (males) after a number of asexual generations. The microgamete will fertilize the macrogamete to produce an oocyst, which is shed unsporulated into faeces, thus restarting the lifecycle.
The resistant walls of the oocysts aids in its survival. Coccidia oocysts have an optimal temperature range of 30 – 40° Celsius, in which they are able to survive more than a year (Spielman n.d.).
Ladds P (2009) Protozoal diseases in terrestrial mammals. In ‘Pathology of Australian Native Wildlife.’ (Ed P. Ladds). (CSIRO Publishing: Collingwood)
Yang R, Fenwick S et al. (2012) Molecular characterization of Eimeria species in macropods. Experimental Parasitology, 132(2): 216-221
Vermeulen ET (2022) Diversity of protozoan parasites in a threatened marsupial (Petrogale penicillata) which is part of a conservation program thesis, Macquarie University
Wildlife Health Australia (March 2025) Coccidiosis in Australian Marsupials and Monotremes Fact Sheet
https://wildlifehealthaustralia.com.au/Portals/0/ResourceCentre/ FactSheets/Mammals/Coccidiosis_in%20_Australian_marsupials_and_ monotremes.pdf
Spielman, D. (no date) Coccidiosis in macropods and other species https://www.awrc.org.au/uploads/5/8/6/6/5866843/34_ spielman_-_coccidiosis_in_macropods_and_others.pdf
Cathie Harvey Veterinarian
Tauwitchere Pastoral Co
Narrung SA
e. CJH@tpcorganic.com.au
Jeremy Rogers
Senior Veterinary Officer
PIRSA, Murray Bridge SA.
C&T No. 6126
Introduction
A commercial beef cattle producer found two young (2-year-old) bulls dead in a paddock, and afterwards a young heifer later also died in that paddock.
In all cases the animals were fine in the evening and found dead the next morning. Sudden deaths of adult cattle are very rare in this area, and the rapid decomposition of the bodies led the owner (a veterinarian) to suspect clostridial causes. Since recommended vaccination for cattle was performed, Paeniclostridium sordellii (formerly Clostridium sordellii ) was suspected, and subsequently isolated.
This is a rare diagnosis in SA, but may occur more frequently than is realised. Unfortunately, there is no vaccine registered in Australia for this, but following some previously described cases, one veterinarian believes he has success in using a commercial vaccine.
Thorough investigation of unusual cases builds our understanding and knowledge about causes, and is a helpful rule out for some exotic diseases.
In early July, two young bulls were found dead within 24 hours of each other in a paddock that is only irrigated once per year. The bodies seemed to bloat and decompose very rapidly, despite cold and winter conditions. All cattle were moved off the paddock and then a mob of yearling heifers were moved onto the
paddock on 9/9/2025. One of these heifers was found dead next morning with the same blown-up appearance. A bloody discharge around the mouth and vulva was observed and the animal had a putrid smell.
The owner, a veterinarian, contacted PIRSA for advice and assistance in an investigation, and to rule out anthrax. This animal tested negative for anthrax on ICT (immunochromatographic test).
The paddock did not appear to have any known toxic plants and was well managed. All cattle were vaccinated according to manufacturer’s recommendation with standard Clostridial vaccines (5 in 1). The owner recalls 1 or 2 deaths previously in steers and because the animals were unusually blown up in cooler weather, these deaths were put down to bloat.
A range of samples were collected from the most recent case, the dead heifer. No significant histopathological findings were found in liver, heart, spleen, kidney, skeletal muscle, large intestines, mesenteric lymph nodes, lung. Paeniclostridium sordelli was cultured from intestinal contents, heart and muscle. The laboratory findings in conjunction with the history are suggestive of, but do not confirm, death due to Paeniclostridium. sordellii. Paeniclostridium sordellii has been associated with unexpected deaths / found dead / sudden death in cattle. 2
Paeniclostridium sordellii spores are found in the intestinal tract of healthy animals and they will proliferate postmortem in the intestines and other organs. Therefore, if there was likely > 2-3 hours from death to necropsy, a positive culture from the intestines and muscle should be interpreted cautiously.
Paeniclostridium sordellii has been described in SA previously only twice, in 2020 and 2021, but Australian literature on Paeniclostridium sordellii is sparse, although anecdotes report that feedlot cattle can die from this source.
One American source describes ‘Sudden Death Syndrome (Clostridium sordellii )’ C. sordellii is commonly associated with ‘sudden death syndrome’ in feedlot cattle. Typically, there are no signs of disease or infection other than the sudden death of one or more animals. Upon necropsy, these animals exhibit necrosis and massive haemorrhage in the brisket and throat area with little or no gas accumulation. Transmission is not known, but oral transmission is suspected.³
Investigations of animal deaths can be most frustrating at times when, for a range of reasons, appropriate samples cannot be collected and tested, or there are very few

clinical signs to observe. In this case, since clostridial diseases tend to be associated with rapid feed or diet changes in ruminants it may be wise to take this into account with young, fast-growing cattle.
In this case, other Clostridium species were also cultured from heart and subscapular muscle tissue, but it is suspected that these may have been secondary postmortem invaders.
Treatment and prevention are problematic as the course of the disease is very rapid, and there is no registered vaccine available in Australia that includes this organism. However, a veterinarian involved in the 2020 and 2021 cases has recommended using Tasvax 8 in 1, (Coopers) on previously affected properties, with apparently good results. Label claims are :
‘For active immunisation of sheep against Pulpy Kidney, Lamb Dysentery, Malignant Oedema/Gas Gangrene, Blackleg, Black Disease, Tetanus, Swelled head in rams and post parturient gangrene in ewes. Cattle: For active immunisation of cattle against Pulpy Kidney, Haemorrhagic Enterotoxaemia, Malignant Oedema, Blackleg, Black Disease, Redwater and Tetanus ‘Subcutaneous injection only. Cattle 5mL per head initially twice 4-6 weeks apart followed by annual booster.’

The Tasvax 8 in 1 vaccine prevents diseases caused by the following bacterial species (all Clostridium species):
– Clostridium chauvoei (causes blackleg)
– Clostridium haemolyticum (causes bacillary hemoglobinuria, red water)
– Clostridium novyi Type B (causes black disease or infectious necrotic hepatitis)
– Clostridium perfringens Types B, C, and D (causes lamb dysentery, hemorrhagic enterotoxemia, pulpy kidney)
– Clostridium septicum (causes malignant
– Clostridium tetani (causes tetanus)
Presumably, this large number of clostridial exotoxins cross reacts with the toxins of Paeniclostridium sordellii.

1. Hungerford’s Diseases of Livestock 9th Edition 1990 McGraw Hill Book company
2. Vermunt JJ, Malmo J, Parkinson TJ, Laven R. Causes of Sudden Death. In: Vermunt JJ , Parkinson TJ, Laven R, editors; Diseases of Cattle in Australasia : A comprehensive textbook. New Zealand Veterinary Association Foundation for Continuing Education, Wellington 2019
3. Clostridial Diseases of cattle - Ashley Wright University of Arizona libraries.

Join Clara Goh and Trent Gall for a brand-new 2-day hands-on CVE workshop designed to provide specialistlevel guidance in common soft tissue and orthopaedic procedures performed in general practice.
This intensive workshop combines lectures, case-based videos and extensive lab time, with a small-group format and high tutor-to-participant ratio that allows for personalised guidance, on-the-spot feedback and more direct support from the tutors.
Participants will strengthen technique, improve efficiency and build confidence across a range of canine and feline procedures.
13 – 14 June 2026 | 20 CPD Points
The University of Sydney
Member Early Bird closes 19 April 2026
As Director of CVE, I believe we have both a responsibility and a privilege to bring complex, and sometimes uncomfortable, conversations to the forefront of the veterinary profession. We see thought leadership not as telling the profession what to think, but as creating a credible, evidence-informed space where diverse perspectives can be explored respectfully. Many of the challenges facing veterinary medicine are rarely straightforward; they sit at the intersection of clinical judgement, regulation, ethics, public expectation and lived experience. Debate about the use of a prohibited drug in a species classified for human consumption - when the individual bird is also a much-loved pet, is one such example. It surfaces tensions between legal frameworks, animal welfare, professional integrity and personal values. Our role is not to advocate for breaching the law, but to facilitate rigorous, balanced discussion that makes these complexities accessible, highlights the range of professional viewpoints, and examines how such dialogue can inform policy, guide decision-making and strengthen collective understanding. This is precisely why C&T exists: to surface nuanced questions, make complexity accessible, and invite the profession to engage thoughtfully. We encourage colleagues to engage in this conversation with curiosity and respect, and to share their experiences, recognising that thoughtful debate is one of the most powerful tools we have to advance our profession.
_Kate
Anonymous
C&T No. 6127
Identification
Turkeys with blackhead disease usually start off by displaying some physical changes. They appear listless and have drooping wings and unkempt feathers.
Loss of appetite is another early indicator. Turkeys generally have great appetites.
It is always difficult to know whether it’s just general parasite load, coccidiosis or blackhead disease without test results. Unfortunately, due to the rapid progression of the disease, it’s difficult to get test results back in time.
Within a day or two from first observations, the faeces change, progressing from a firm brown blob with white cap to a sloppy dark green mass.
If left untreated for a few more days the faeces develop a watery bright yellow, almost fluorescent appearance –(Figure 2).
Treatment
If left untreated, the turkey usually dies within 5-7 days. Poults will die within 2-3 days.


I generally start treatment when I notice the faeces change from normal feces to that as shown in Figure 2 Timely intervention is critical for success.
I. First step is to isolate the turkey into a treatment pen.
II. Administer Metronidazole, 200mg tablets broken in half pieces and placed in the gullet.
Day 1 One and a half tablets (300mg), broken into 3 half tablets. Two half tablets (200mg) given as first dose, then 12 hours later 1 half (100mg) placed in the gullet.
Days 2 – 4 Two x half tablets (200mg) given as a dose each morning.
Note – much better to give ½ tablets than full tablets.
Generally, by Day 3, appetite has resumed and colour of faeces changes to a brownish appearance.
By Day 7, the turkey appears normal in appearance with a good appetite. I release the bird back into the flock after several days of normal faeces.
All turkey are monitored for any changes in physical and faeces appearance. I treat birds that appear in early stages of the disease with 1 tablet 200mg, broken into half pieces daily for 3–4 days.
Histomoniasis (blackhead disease) is caused by the protozoan parasite Histomonas meleagridis, a flagellated protozoan that infects the caeca and liver of gallinaceous birds and leads to necrotic typhlitis and hepatitis, with mortality in turkeys frequently reaching 80–100% in susceptible flocks (Beer et al. 2022). Turkeys are typically more severely affected than chickens, in which disease can be subclinical or less severe, although recent evidence suggests pathogenic impacts in chickens too (Beer et al. 2022).

Transmission of H. meleagridis is closely linked with the caecal nematode Heterakis gallinarum, in whose eggs the protozoan can persist and remain viable in the environment for long periods (McDougald 2000; Trees 2008). Earthworms and other paratenic hosts that ingest infected nematode eggs can further mediate indirect transmission to poultry, particularly in free-range or backyard systems where birds have access to soil organisms (Beer et al. 2022; CSIRO Publishing 2025).
In addition to vector-mediated transmission, H. meleagridis can spread by direct transmission, likely via cloacal contact among infected birds, facilitating rapid spread through turkey flocks once introduced (Clark and Kimminau 2017; McDougald 2005).
The pathogenesis involves severe inflammation and necrosis of the caecal mucosa, followed by translocation of the parasite and secondary bacteria to the liver where characteristic target-like lesions develop.
A major challenge in current clinical practice is the lack of licensed antihistomonal drugs or vaccines in many jurisdictions, including Australia, following regulatory withdrawal of effective agents such as nitroimidazoles and nitarsone in the EU and North America (Clark and Kimminau 2017; Beer et al. 2022). This gap forces reliance on management, biosecurity, and worm control to reduce exposure risk and environmental contamination (Beer et al. 2022).
Recent research has explored alternative control strategies, including phytogenic compounds and liveattenuated vaccine candidates, showing promising results in experimental settings but requiring further validation for field use (Beer et al. 2022).
The interplay between H. meleagridis and other enteric pathogens such as coccidia may exacerbate lesion severity and disease outcome, suggesting a role for

integrated enteric health management in reducing clinical impact (Marchello et al. 2001).
Given the resurgence of histomoniasis following the removal of effective compounds and the increasing prevalence of free-range production systems worldwide, including Australia, veterinarians should maintain a high index of suspicion for histomoniasis in turkeys presenting with rapid onset depression, anorexia, and characteristic faecal changes. Early intervention focusing on environmental control, worm management, and separation from other galliform hosts (e.g. chickens) remains central to outbreak control and mitigation.

Beer, L.C., Petrone-Garcia, V.M., Graham, B.D., Hargis, B.M., Tellez-Isaias, G. and Vuong, C.N. (2022) Histomonosis in Poultry: A Comprehensive Review, Frontiers in Veterinary Science, 9, p. 880738. doi: 10.3389/ fvets.2022.880738.
Clark, S. and Kimminau, E. (2017) ‘Critical Review: Future Control of Blackhead Disease (Histomoniasis) in Poultry’, Avian Diseases, 61(3), pp. 281–288. doi: 10.1637/11593-012517-ReviewR.
McDougald, L.R. (2005) ‘Blackhead Disease (Histomoniasis) in Poultry: A Critical Review’, Avian Diseases, 49(4), pp. 462–476.
Marchello, J.A. et al. (2001) ‘Blackhead disease (Histomonas meleagridis) aggravated in broiler chickens by concurrent infection with cecal coccidiosis (Eimeria tenella)’, Avian Diseases, 45(1), pp. 177–181. PubMed ID 11417809.
Trees, A.J. (2008) Protozoa: Histomoniasis, in Poultry Parasites, Pathology and Protection. CSIRO Publishing.
BVS Fellow (FANZCVS) Avian Medicine
This article provides a broad but clear background to the disease ‘Blackhead’ (caused by Histomonas meleagridis) in turkeys and peafowl. In particular, his description of the protozoan’s life cycle, and that of its intermediate host, Heterakis gallinarum, is vital in understanding this disease and its treatment and control. The importance of chickens in spreading this disease (although asymptomatic) is touched upon briefly, but needs to be a focus for veterinary intervention.
Unfortunately, this article over-simplifies the diagnosis and treatment of this disease. In my experience, this is often a diagnosis made on necropsy. The signs of the disease described in the article are very non-descript— coming under the umbrella of ‘SBL’—Sick Bird Look. The characteristic liver ulcerations and necrotising typhlitis have to be visually identified, then confirmed by histopathology, to reach a conclusive diagnosis.
Treatment of this disease is difficult—not because of the difficulty confirming a diagnosis—but because of the legalities around the choice of suitable medication.
‘The use of antibiotics is under increasing scrutiny, particularly in food-producing animals, because of the possibility of the occurrence of human health hazards due to antibiotic residues, development of antibiotic-resistant bacteria or resistance genes in food. Veterinarians are the trained professionals who are expected to oversee the prudent use of antibiotics in birds.’1
The Australian Pesticides and Veterinary Medicines Authority (APVMA) recognises the following foodproducing animal species under its regulatory framework
¹ Australian Veterinary Association. Guidelines for Prescribing, Authorising and Dispensing Veterinary Medicines. Version 4 , February 2005. Updated September 2008, September 2009, & October 2013. Appendix 15 Updated October 2023
Mammals
– Cattle
– Sheep
– Goats
– Pigs
– Deer
– Buffalo
– Camelids (e.g. alpacas, camels)
Poultry
– Chickens
– Turkeys
– Ducks
– Geese
– Quail
– Other farmed poultry species
Aquaculture Species
– Finfish (e.g. salmon, trout, barramundi, tuna)
– Crustaceans (e.g. prawns, yabbies)
Other Species
– Honeybees (for honey production)
– Molluscs (e.g. oysters, mussels)
The APVMA also lists prohibited drugs, i.e. medications that cannot be used in food-producing species. These drugs are:
– Carbadox
– Chloramphenicol
– Clenbuterol (except for tocolysis as per the APVMAapproved label)
– Diethylstilboestrol and related compounds (hexoestrol, dienoestrol)
– Fluoroquinolones
– Nitrofurans (including furazolidone and nitrofurazone)
– Nitroimidazoles (except dimetridazole for use on birds not intended for human consumption and breeders, as per the APVMA-approved label)
– Phenylbutazone
– Salbutamol
– Thyrostats (e.g. thiouracil)
Note that, under these lists, turkeys are considered a food-producing species, and metronidazole (although effective for Blackhead) cannot be used in them.
Metronidazole is not permitted for use on food-producing animals in Australia due to its carcinogenic potential. The prohibition is a critical public health measure to
prevent potentially harmful drug residues from entering the human food supply. The ban extends to the entire nitroimidazole class of drugs, including dimetridazole and ipronidazole, to ensure comprehensive food safety. Regulatory enforcement by agencies like the FDA strictly prohibits extra-label use of metronidazole in food-producing species.2
What about ‘off label use’ or ‘minor use’ for backyard or show turkeys?
Minor use of a drug, under the APVMA framework, is the use of a registered product for a species or purpose that is not on the approved label, typically because the market is too small for the company to register it commercially. Sounds promising, but further reading reveals that minor use has to be formally authorised by the APVMA via a permit.
Metronidazole in turkeys is not a minor use issue —it is a prohibited substance issue.
Off-label use, on the other hand, is the use of a registered product outside the label directions, relying on state/territory legislation (where allowed) rather than a federal permit.
BUT—its use must comply with APVMA restrictions and any label restraints, and it cannot result in unacceptable chemical residues. In food-producing animals, offlabel use can be legally complex because withholding periods and maximum residue limits (MRLs) must still be met. Off-label use may be permitted for some veterinary medicines —but not for substances specifically prohibited in food-producing animals.
Even if a turkey is originally kept as a pet or show bird, it may later be given away, sold, used for eggs, or processed for meat. Residue liability may still arise. How can a veterinarian be confident the animal will not later enter the food chain?
In a nutshell, even if we are talking about small flocks, raised as show birds, pets, or backyard food-producers, turkeys are legally food-producing animals.
For the use of metronidazole:
– There is no approved label claim for its use
– There are no minor use permits for its use
– The substance is internationally restricted
– Residues pose a public health concern
– There are no established MRLs for turkeys, therefore a veterinarian cannot legally assign a withholding period to make it compliant
² APVMA website
The sum of all this:
Metronidazole cannot legally be used, even off label, in turkeys.
And it’s not just metronidazole – none of the nitroimidazoles (e.g. ronidazole) can be used. Treating Blackhead is made difficult by the law, and throws the spotlight on to prevention (through managing mixed species flocks, pasture management, and parasite control) —but isn’t that the whole objective in antimicrobial management.
There is an important distinction between Australian Heritage Turkey varieties (9 only) and broad breasted turkeys which are bred specifically for consumption.
The broad breasted whites are a genetically modified bird—fast weight gain with a view of harvesting them between 12-16 weeks. They struggle to live beyond 26 weeks. Their bodies are too heavy for their legs, strain their organs and they generally cannot breed naturally— they are artificially inseminated.
Australian Heritage Turkey varieties are long-lived birds up to around 12 years. They don’t grow as big, and they’re not destined for the meat market. They are mostly kept by fanciers who are committed to the preservation of the 9 purebred turkey varieties here in Australia. They breed naturally.
For information, there are only 26 breeders across Australia, but less than 10 committed breeders of multiple varieties. Most recognised breeders only breed 1 to 2 varieties. They are required to breed pure to the Standards.
When looking at the committed breeders who have 4 or more varieties under their care, these are not people who produce for the commercial turkey meat market. They work as a group and share genetics to improve pure lines. There are so few breeders for particular varieties e.g. Bourbon Reds—only 4 breeders across Australia. Blue variety—only 2 breeders across Australia.
It is imperative that we keep these turkey lines healthy to ensure their survival. If we don’t, the gene pool shrinks and is at risk of extinction here in Australia.
The speed at which disease can spread once it has been established should not be underestimated. Most keepers do not have access to laboratory facilities, specialist training, or the legal authority to test and diagnose birds, and are often limited in what they can do once a bird becomes ill.
Suggestions such as using ‘sterile’ pasture can be difficult to apply in practice. If a chicken or other infected bird has crossed that ground at any time in the past several years, there may be a risk of transmission. Similar concerns arise when introducing new birds, as they may carry infection without showing symptoms.
An alternative approach—raising turkeys in a fully sterile environment with raised wire flooring—can bring its own health and welfare challenges. In addition, if an infected bird enters such a system, the environment can no longer be considered sterile.
More information can be found at https://turkeysaustralia.tidyhq.com/
CVE Valentine Charlton Consultant
e. Richardmalik@sydney.edu.au
The veterinary oath, professional duty and the treatment of heritage turkeys with histomoniasis in Australia
The oath taken by veterinary graduates in New South Wales, including at the University of Sydney, states:
"I solemnly swear to practise veterinary science ethically and conscientiously for the benefit of animal welfare, animal and human health, users of veterinary services and the community. I will endeavour to maintain my practice of veterinary science to current professional standards and will strive to improve my skills and knowledge through continuing professional development. I acknowledge that along with the privilege of acceptance into the veterinary profession comes community and professional responsibility. I will maintain these principles throughout my professional life.
For clarity and international comparison, the widely cited North American oath reads:
"I solemnly swear that I will practise my profession conscientiously and with dignity and in keeping with the principles of veterinary medical ethics. I will use my scientific knowledge and skills for the benefit of society through the protection of animal health and welfare, the prevention and relief of animal suffering, the conservation of animal resources, the promotion of public health and the advancement of medical knowledge.
Read together, and interpreted in an Australian regulatory setting, these oaths make one point unmistakably clear: veterinary medicine is a profession that requires the exercise of ethical judgement in circumstances where duties are in tension. They do not reduce the veterinarian to a passive instrument of regulation. They impose a personal, continuing responsibility to act conscientiously, to apply current science, to protect animal welfare and to serve the community.
In the case of histomoniasis in heritage turkeys, the conflict is not theoretical. It is immediate and clinical. The disease is rapidly progressive, produces profound systemic illness and has a very high mortality rate in untreated birds. Effective therapy is well known, inexpensive and familiar to the profession. The veterinarian is therefore confronted with a conscious animal whose suffering and death are both predictable and preventable.
Australian law classifies turkeys as food-producing animals, and the prohibition on nitroimidazoles exists to protect the human food chain. That public-health objective is legitimate and important. However, the NSW oath does not instruct the veterinarian to apply regulatory categories without thought to biological reality. It requires practice ‘ethically and conscientiously for the benefit of animal welfare, animal and human health … and the community.’ The key word is conscientiously. Conscience in professional life is not a feeling; it is the obligation to weigh competing duties and to act in a manner that is proportionate, transparent and defensible.
Heritage breeding turkeys in Australia occupy a category that is legally simple but biologically and ethically complex. They are not commercial meat animals. They are long-lived, individually managed, genetically significant birds maintained for conservation breeding in very small national populations. Their value lies in their continued life and reproductive capacity, not in slaughter. They can be permanently and verifiably excluded from the human food chain. In any meaningful public-health analysis the residue pathway is therefore theoretical, remote and controllable, while the animal welfare consequence of non-treatment is immediate, certain and severe.
To practise to ‘current professional standards’ in such a case is to recognise the pathogenesis of the disease, the clinical outcome without therapy and the efficacy of treatment. Contemporary veterinary standards in Australia place animal welfare at the centre of clinical decision-making. Allowing a treatable animal to die when effective therapy exists is not neutral conduct. It is a decision that must be ethically justified. The
oath requires the veterinarian to accept ‘community and professional responsibility.’ That responsibility is not discharged by allowing preventable suffering in a conservation population in order to manage a hypothetical future exposure that can in practice be eliminated by permanent exclusion from the food chain and full documentation.
When viewed through the longer North American oath, which articulates the same professional values in more expansive language, the alignment is even clearer. The prevention and relief of animal suffering, the conservation of animal resources and the promotion of public health are not mutually exclusive aims. In this Australian context, treating a heritage breeding bird and permanently removing it from any possibility of slaughter protects animal welfare, preserves a rare genetic resource and poses no credible threat to the community. Public health is not advanced by the death of non-food conservation animals. Animal welfare and conservation, however, are directly served by treatment.
This is therefore not casual non-compliance with a regulatory framework. It is an instance of conscientious professional judgement in a wicked problem where two legitimate goods—food-chain protection and the relief of suffering in a non-food conservation animal—collide. Ethical civil responsibility in such a case lies in acting openly, recording the decision, ensuring permanent exclusion of treated birds from the food chain and being prepared to defend the reasoning before professional peers or a tribunal if required.
The NSW oath emphasises that the privilege of belonging to the profession carries responsibility to the community. The Australian community expects veterinarians to prevent suffering where they can, to preserve endangered and heritage animal populations and to act on the basis of science rather than administrative convenience. A veterinarian who treats a life-threatening disease in a heritage turkey under conditions that remove any realistic public-health risk is not betraying that trust. That veterinarian is fulfilling it.
To refuse treatment in such a case is also a deliberate act. It is an act that permits the avoidable death of a sentient animal, the loss of irreplaceable breeding stock and the erosion of a rare genetic population. It elevates a legal classification above clinical reality and above the sworn commitment to practise ethically and conscientiously for the benefit of animal welfare.
In the Australian context, and under the oath actually taken by graduates in New South Wales, the coherent and professionally defensible course is to treat. That course does not deny the importance of public health or the authority of the regulatory system. It applies them
proportionately, in a way that is scientifically grounded, ethically transparent and faithful to the obligations the veterinarian has personally sworn to uphold.
According to the Poultry Hub Turkey - Poultry Hub Australia ‘There are two species of wild turkey: the North American Wild Turkey (Meleagris gallopavo) and the Central American Ocellated Turkey (M. ocellata).’
According to the Australian Heritage Turkey Society’s website Australian Heritage Turkey Society | Australian turkeys ‘Unlike chickens, ducks and geese, which are made up of a number of different breeds, domestic turkeys comprise but one breed, with a number of varieties. The Australian Poultry Standards (2nd edition) recognises nine varieties.’
So, it would seem that there is only one turkey species in Australia, the North American Wild Turkey ( Meleagris gallopavo) and that selective breeding has produced not only the meat turkey, but also nine varieties based, I suspect, on their colour. The meat turkey is the result of genetic selection, not genetic modification. The heritage turkeys are the same, but using different criteria for selection.
So, claiming exemption from APVMA prescribing regulations based on the colour of the turkey is similar to claiming an exemption for your Jersey cows based on differences in colour. The author states that heritage turkeys are not destined for consumption. Based on his further statement that ‘ there are only 26 breeders across Australia, but less than 10 committed breeders of multiple varieties. Most recognised breeders only breed 1 to 2 varieties. They are required to breed pure to the Standards.’ I would argue that most vets will never see one of these colour varieties, and can only assume that any turkey they are presented with, could enter the food chain. I notice that the author makes no

comment regarding the eventual outcome of surplus stock, or birds not up to the Standards. I doubt they end up as landfill.
Richard has commented on the ethics of treating the individual vs treating the many (and following the law), presenting valid and conscientious arguments. This is an ethical quandary that every vet treating backyard poultry grapples with on a daily basis. Nevertheless, the law is quite definite on this point. If a veterinarian decides to disregard the legislation that is in place for the greater good—whether they disagree with it or not—that decision is theirs alone to make. Just so long as they understand that, if something goes pear-shaped, they hold the liability alone. Neither professional organisations nor drug manufacturers will be in a position to assist. Richard’s final comment: It applies them proportionately, in a way that is scientifically grounded, ethically transparent and faithful to the obligations the veterinarian has personally sworn to uphold. sounds good in theory but is difficult to reconcile with ‘community and professional responsibility’.
I would also remind veterinarians that euthanasia of an animal that is suffering is, in its own right, a legitimate form of treatment.
20 April - 17 May 2026 | 15 CPD Points
Bob Doneley BVSc FANZCVS (Avian Medicine)
…Bob's opinions and views on life and poultry were enlightening and I now approach my avian patients with enthusiasm rather than fear. Thanks.
_Liz Brown, 2023 Course Participant

Dr Andrea M Harvey BVSc PhD DSAM(Feline) DipECVIM-CA MRCVS MANZCVS (Animal Welfare)
Associate
Professor
in
Veterinary Medicine and Animal Welfare Science
Sydney School of Veterinary Science
The University of Sydney
I just wanted to capture readers’ attention, as if you don’t practice any equine dentistry it would be easy to skip past this article thinking that it wasn’t relevant for you. So I just wanted to point out why it is relevant for all vets.
Although I have trained as a feline medicine specialist, I have maintained an interest in just about every aspect of veterinary medicine and as well as cats, I regularly treat common conditions in an array of other species including sheep, goats, cows and horses. Through doing this I am constantly amazed and reminded about how so many things come down to basic first principles, being highly observant with attention to detail, having analytical critical thinking, and adopting a logical approach. And in doing so, how much you can learn from other species and other disciplines that apply to so many things that you may be doing every day.
I also really enjoy chatting with skilled knowledgeable colleagues in other disciplines as almost every conversation can lead to learning something that is relevant to your own discipline. Shannon is a great example of this; highly knowledgeable and skilled and the ultimate Sherlock Holmes of the equine oral cavity! With a good examination being the foundation of good clinical decision making, Shannon can detect the most subtle clues for dental pathology. More than being one of Australia’s most experienced and skilled equine veterinary dentists, something that sets Shannon apart is being a master of the fundamental skills that are common to all areas of veterinary medicine,
namely observation, a good examination, attention to detail, critical thinking, working from first principles and a logical approach. With the rise of available knowledge and equipment, it is important not to forget these basic skills that are the foundations of veterinary science whatever species or discipline you are working in.
In this digital age, it is phenomenal that advice on cases can be accessible from leading experts all around the world. However, the quality and accuracy of the advice you may get is only as good as the information that you provide. This is certainly the case for equine dentistry, highlighting the importance of this article to anyone doing equine dental work. But some of Shannon’s points apply equally to capturing other images of any species, and other points apply generically to other aspects of patient records—for example ‘will someone else looking at your records be able to quickly get a good enough grasp of the case without any further information’. Good medical records and communication are key to getting good advice on any species in any discipline—rarely will good advice come from a 2-line message or a single image.
So don’t dismiss reading the next article if you don’t do any equine dentistry, because there are important points that equally apply to small animal (and other mixed) practice. And if you do perform any equine dentistry this article is definitely not to be missed, as it provides you the tools to obtain helpful advice from top experts wherever you are dealing with your case. Remember though, as with all cases no matter what the species or discipline, advice is always most helpful early on in the management of a case rather than waiting until something has gone wrong!
Winner - Best Visuals
Entitled to a a CVE$300 voucher
Dr Shannon Lee
Advanced Equine Dentistry
482 Galston Road, Dural NSW 2158
t. 61 418 598 621
e. vetbloke@hotmail.com
C&T No.
More than ever, images are captured and shared, whether in patient records, with clients, or among colleagues. Images can convey a great deal of information and applying simple principles can improve their quality and increase their value when stored or shared.
Images are of value in documenting patients and findings as well as aiding comparative assessment for future exams. They can allow effective input and advice on cases and conditions remotely, and in the case of referral, they can assist in providing details on the case for review prior to or following assessment and or treatment.


There are several categories of dental image that a clinician may find useful:
– Extra oral images
– Intra oral images
– Specimen images
– Annotated images
Equipment will vary between practitioners and will change over time; however, the key elements remain the same. It is common for clinicians to apologise for their images or attribute poor quality to a lack of expensive or advanced equipment. In my experience of acquiring and reviewing images as technology has evolved, producing clear, detailed, and usable images depends far more on good technique and basic equipment than on high-end technology. Advanced equipment cannot compensate for poor technique or setup.
First, a camera capable of capturing images and video at sufficient quality and resolution is essential. Most modern mobile devices are suitable for this purpose, with smartphones generally preferable to tablets due to their size and ability to get closer to the mouth for intraoral images.
In addition, equipment which allows detailed examination of the head and mouth is required. This includes





Lips not retracted

Lips now retracted image still too far away

Light and speculum in the way (image too far away)

Poor positioning looking at tongue
appropriate head support, speculums for the incisor teeth and oral cavity, a suitable light source, a dental mirror, a device for retracting soft tissues such as the tongue, and tools to clean the area of interest before image capture.
First, consider what you are trying to capture or convey. This should be clearly shown in the images obtained. When reviewing your images, think about what information they provide when viewed on their own, without the patient or additional context.
As clinicians are often busy, it can be tempting to capture images as quickly as possible. However, image quality— together with any accompanying information—has a direct impact on the ability of other clinicians to offer advice and on the usefulness of that advice. Taking time to obtain images of appropriate quality and detail, and to include relevant notes or supporting material, benefits all parties involved.
Image acquisition often occurs at the time a problem is identified. However, as with other forms of imaging such as radiographs, it can be helpful to consult colleagues in advance about what images they would find most useful. They may also be able to review existing images and suggest additional views. Over time, this approach can streamline the process and make communication more efficient for everyone.
In photography, several simple—but not always easy to achieve—principles form the foundation of good technique in both image capture and image review.

Basic photo of upper cheek teeth

Light in the way and light is blurry distraction/ artifact
y Focus refers to how sharp an image appears. This is closely linked to depth of field (DoF), which determines how much of the image is in sharp focus. A small depth of field produces a limited area of sharpness, whereas a large depth of field keeps more of the image in focus.
y The amount and location of sharp focus required will depend partly on other factors in image capture, such as the size of the area of interest relative to the overall image.
y It is also influenced by the level of detail that needs to be recorded and conveyed accurately.
y Consider the presence of any distracting elements and whether they should be included in, or excluded from, the focused area.
y Most devices used to capture images have one or more forms of autofocus. Understanding how autofocus works on your device can significantly improve image quality. As a practical tip, select your point of focus by tapping the screen (on mobile devices) or half-pressing the shutter button (on cameras) and then recomposing the image so the area of interest is centred. Compare this with an image taken without selecting the focus point to see which produces the better result.
y Composition refers to how elements are arranged within an image. Poor composition can introduce distractions; for example, when the aim is to capture


the surface of a specific tooth but the patient’s lip occupies the foreground and distracts the viewer.
y Composition varies between practitioners due to individual styles and because 3-dimensional structures must be represented in 2-dimensional images. In some situations, video can offer advantages over still images by better demonstrating spatial relationships. As a general guide, the area of interest should be clearly visible, prominent, and free from distractions or artefacts.
y In most cases, the area of interest should be positioned near the centre of the image with unnecessary elements excluded. Where scale is important—such as when recording swellings or documenting tissues after extraction—placing an appropriate reference object within the image can be very helpful.
3. Lighting
y Lighting determines how clearly the subject of the image is seen and how accurately colours and details are represented. Poor lighting can obscure important features or create unwanted shadows and glare.


y Natural light is often ideal, but it may not always be practical. Consistent, even artificial lighting can also produce excellent results, especially for intra-oral or clinical images.
y Consider the direction, intensity, and colour of the light. Avoid harsh overhead lighting that casts deep shadows and try to ensure the light highlights the area of interest without creating reflections or glare.
y When using cameras or mobile devices, be aware of features like flash, exposure compensation, and white balance, as these can significantly affect image quality. Testing different lighting setups can help determine what works best for your specific needs.
y See the three images of the same subject in Figure 3 and compare them. One is taken in bright light, one in mixed light and shadow, and one in complete shade. The shade was achieved in this image by having a second person hold an item between the light source, in this case the sun, and the area to be photographed.
4. Depth of field
y Depth of field (DoF) determines how much of an image is in sharp focus. A shallow DoF results in only a



small area being sharp, while a larger DoF keeps more of the image in focus.
y In the examples shown, Image 4A has the main area of interest out of focus due to a limited depth of field, causing a loss of detail. Image 4B, in contrast, shows both the area of interest and the surrounding structures in focus, thanks to an increased depth of field.
y Controlling DoF is essential to ensure that the area of interest is clearly visible while maintaining an appropriate level of context in the surrounding image.
5. Artifact
y In this context, artifacts refer to elements in an image—such as reflections from lighting or moisture— that distort or alter its appearance, potentially mimicking pathology.
y For example, reflected light from an intra-oral endoscope at certain angles can make it appear that occlusal dentine is absent on a cheek tooth, even though it is present.
y Being aware of potential artifacts and adjusting lighting, angles, or moisture control can help minimise their occurrence and ensure that images accurately represent the area of interest.
y Comparing images with and without artifacts can be a useful teaching tool for understanding how to avoid them in practice.
See images (5A and 5B) with too little contrast and with a balance of contrast

7. Distraction
y In this context, distractions are any elements in an image that reduce clarity or make interpretation more difficult.
y For intra-oral and dental photography, preparation and cleanliness are essential. Food debris, saliva, blood, or water not relevant to the condition being documented should be removed before capturing the image.
y There is overlap between distractions and artifacts. Common causes include damage to the dental mirror (scratches, pitting, cracks, or tape used on the mirror surface) or failure to clean and prepare the mirror, which can lead to fogging. Using a clean, scratch-free mirror and preparing it properly prevents these issues. Replace mirrors as needed to maintain image quality.
y Comparing images with and without distractions helps highlight their impact on clarity and interpretation.
1. Patience is key
y Dental photography, particularly intra-oral imaging, can be challenging and requires preparation and patience. Time pressures, patient management, client communication, and technology issues can all create frustration. Taking the time to manage these effectively remains the single most important factor for improving image quality.
2. Eliminate or control movement
y Controlling movement is critical for producing clear images with the desired composition. Key factors include patient management and, when appropriate, the use of sedatives or analgesics. Sedatives may affect posture or produce ataxia, so additional support for the patient is important.
y For images of the mandibular dental arcades, controlling tongue movement is essential. This can be aided with diazepam to produce temporary flaccidity and the use of retractors.
y Example: (Figure 7) A needle placed in a fistula as a radiometallic marker shows improved clarity when a tongue retractor and diazepam are used, even without a dental mirror.
3. Have extra pairs of hands
y While high-quality intra-oral images can be taken solo, assistance improves repeatability and efficiency. Ideally, three people are involved: the clinician operating the camera and mirror, and assistants managing retractors, soft tissues (lips and tongue), and any other aids (probes, explorers, markers).
4. Prepare equipment carefully
y Ensure all devices—lights, cameras, tablets—are charged and ready. Keep retractors, probes, explorers, and mirrors within easy reach.
y Dental mirrors should be clean, scratch-free, prepared with anti-fog solution, and replaced when damaged. The same applies to screens and oral scopes.

5. Consider occupational health and safety
y Dental photography may involve large, reactive patients and multiple people. Ensure safety for all participants by anticipating potential risks and taking necessary precautions.
6. Record normal as well as pathology
y Like radiographs, recording normal structures alongside pathology is often important. Documenting the unaffected areas provides context for comparison, helps identify concurrent disease, and strengthens the diagnostic record.
7. Use markers and measuring aids
y Include rulers, skin markers, or other scale objects to quantify or highlight areas of interest. Taking images from multiple perspectives or using video can help capture three-dimensional structures. Always consider capturing normal areas for comparison.
8. Review images critically
y After capturing images, review them carefully:
à Develop a critical eye to identify strengths, weaknesses, and areas for improvement.
à Select images that best highlight the intended issues. Even if an image is not technically perfect, it may still be valuable if it captures key details.
y Consider the following: Will someone else looking at your records be able to quickly get a good enough grasp of the case without any further information’
à Determine if additional images would be useful, and outline what these would be.
à Decide whether annotations (text, arrows, circles) would aid in highlighting key areas.
y Example: Using markers and image annotations can clearly define areas of interest and aid interpretation.
y Before sending images, consider your existing relationship with the recipient. Have you previously discussed the case with them? The context may differ depending on whether you are seeking advice on a newly encountered issue or consulting someone for the first time about an ongoing case.
y While quick answers may sometimes be obtained via messaging platforms like SMS, it is best to first contact the colleague to ask about their preferred format and any additional information they require.
y Treat the collection and collation of images as seriously as any other part of the medical record. Careful preparation ensures the information you provide is clear, relevant, and useful.
y Developing and maintaining professional relationships is equally important. These connections can provide a sounding board for ideas, constructive feedback, and potential collaboration on cases. Taking these steps will optimise the quality of advice and support you receive.


Are you a veterinarian, nurse, technician or receptionist who schedules elective procedures in your practice?
If so, we invite you to participate in a brief survey about pre-anaesthetic fasting via the link below: https://redcap.sydney.edu.au/surveys/?s=F3LR DAH3F4JRFPJY
This survey is open to veterinarians, veterinary nurses/technicians, and veterinary practice managers of the age of 18 or older and working with dogs and cats in Australia.
Should you wish to contact us about this study, please email Dr Anne Quain: anne.quain@sydney.edu.au
The ethical aspects of this study have been approved by the Human Research Ethics Committee (HREC) of The University of Sydney [ethics reference: 2025/HE001250]


Coloured coded minimum volume extension tubing for use with Syringe drivers
· Luer Lock fitting enables compatibility to all syringe drivers
· Pressure resistant up to 2 bar
· Made with PE (Polyethylene), does not container PVC, DEHP or LATEX
· Small tube diameter (1.0 x 2.0 mm) to reduce residual volume
· Available in 3 colours and two lengths
· Low sorbing properties
· Excellent start-up characteristics
· Kink resistant


